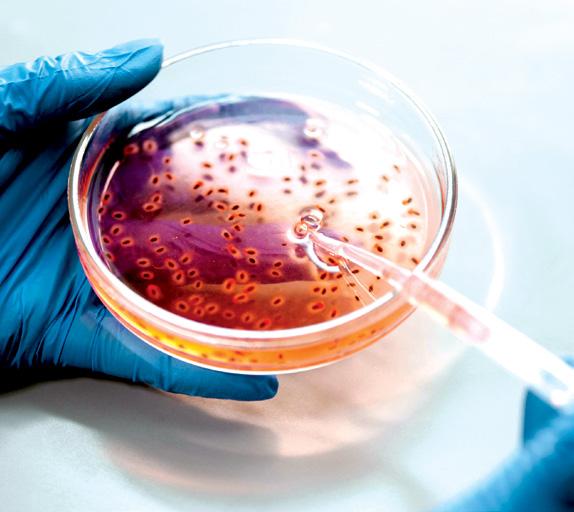

Juntos llevamos las soluciones que las fábricas, establecimientos y negocios necesitan






























































































































































Portada N.º 67
PRESIDENTE - FUNDADOR
Ing. Miguel Ángel Montenegro García PUBLICIDAD & MARKETING
Directora: Lic. Ruth Zurama Rodríguez V. Elva Corayma Neciosup Gonzales
Milagros Rocío Bruno García
Anie Dayana Doroteo Dextre COMERCIAL
Gerente: Carlos Enrique Cáceda Ochoa Jefe: Dámaris Enith Girón Ríos
Asistente: María Celeste Montoya Rojas
Alexandra Lisbeth Duymovich Quispe
Hayla Xiomara Chavez Pascual
Cristhian Jesús Duymovich Quispe INFORMÁTICA & SISTEMAS
Shantall Xiome Gutierrez Huanca
PRENSA & COMUNICACIONES
Jefa: Fiorella Denisse Acevedo Bustillos
Editor: Daniel Edhú Rivera Pérez
Asistente: Yanithza Jesús Mendoza Alvarado AUDIOVISUAL
Coordinador: Ivan Gerardo Melgar Alarcón
Jean Manuel Melgar Alarcón
CURSOS & CAPACITACIONES
Coordinadora: Noemí Cinthia Conde Huamaní ADMINISTRACIÓN & CONTABILIDAD
Administrador: Efraín Montenegro Carrillo CORRECCIÓN DE ESTILO
Rocío Chumbile Vásquez
ARTE GRÁFICO & DISEÑO PUBLICITARIO
Rafael Gonzáles Ascárate
Tatiana Diaz Delgado
Industria Alimentaria es una publicación trimestral de Food & Health Consulting S.A.C. Calle Daniel Cruz 214, urb. La Calera, SurquilloLima - Perú.
El contenido de esta publicación no puede ser reproducido sin nuestra previa autorización. Las opiniones y conceptos emitidos en nuestros artículos son de exclusiva responsabilidad de sus autores.
Contáctenos:
Tel.: (51-1) 448 2340
Cel.: (51) 946 499 333 / 995 292 536
Escríbenos a: info@industriaalimentaria.org
Visítenos en: www.industriaalimentaria.org
Hecho el Depósito Legal en la Biblioteca Nacional del Perú N.º 2013-03472
Impreso por FARI PRINT S.A.C.
Jr. Pomabamba N° 474 - Breña Telf. 01 683 0083
El mercado peruano de alimentos refrigerados y saludables responde hoy a un contexto dual: por un lado, una sociedad cada vez más consciente de su bienestar; por otro, una plataforma logística en consolidación, especialmente en la cadena de frío. Según un informe de Expert Market Research, el sector de functional foods alcanzó un valor de USD 1,86 mil millones en 2024, y se proyecta un crecimiento anual del 3,5 %, llegando a USD 2,62 mil millones en 2034. Alimentado por ingredientes como quinua, maca y lúcuma, el segmento de refrigerados saludables se convierte en punta de lanza de la innovación alimentaria local.
Complementariamente, la cadena de frío en Perú experimenta una transformación acelerada. El mercado de logística en frío alcanzó los USD 120 millones en 2024, con una tasa de crecimiento esperada del 12,1 % entre 2025 y 2034. Las plantas de almacenamiento refrigerado representan el 58 % del mercado, mientras que los servicios de valor agregado (congelación rápida, etiquetado, corte) crecen al 14 % .
Esta sinergia entre la demanda de productos saludables y la infraestructura de frío define el nuevo perfil competitivo nacional: alimentos funcionales preparados, refrigerados y con ingredientes de origen local. Actores peruanos están lanzando líneas de ensaladas, bowls con superalimentos andinos y snacks a base de fruta congelada, buscando conservar frescura y preservar nutrientes esenciales. El segmento de vegetales procesados y congelados generará USD 1 620 millones en 2025.
El Perú avanza hacia un ecosistema alimentario donde lo refrigerado y saludable converge con infraestructura moderna y valor local, apuntando a consumidores cada vez más exigentes. La misión ahora es fortalecer aún más la logística, garantizar la trazabilidad y educar al mercado sobre los beneficios reales de estos productos.
comuníquese al:
www.industriaalimentaria.org
• Actualidad & Tendencias • Nutrición y Salud • Legislación, Calidad y Seguridad • Inocuidad y Saneamiento • Alimentos Refrigerados • Agroindustria al día • Industria Molinera & Panificación • Ingredientes • Innovación y Nuevas Tecnologías • Maquinaria, Equipos & Ingeniería • Pesca y Acuicultura • Envases y Embalajes • Cursos y Eventos

48
““NO BASTA SOLO CON PRODUCIR; HAY QUE GARANTIZAR LA CALIDAD DE LOS PRODUCTOS”

28
LO QUE DEBES CONOCER SOBRE LAS NUEVAS NORMAS DE INOCUIDAD ALIMENTARIA

41
INNOVACIÓN AMAZÓNICA: CÁSCARAS DE CASTAÑA GENERAN ELECTRICIDAD LIMPIA EN MADRE DE DIOS

10
INACAL APRUEBA 10 NUEVAS NORMAS TÉCNICAS PERUANAS PARA FORTALECER LA CALIDAD EN SECTORES PRODUCTIVOS CLAVE
36
LA IMPORTANCIA DE MANTENER LA CADENA DE FRÍO EN EL TRANSPORTE TERRESTRE DE PESCADO Y LA PROPUESTA DE VALOR DE JORLE REFRIGERACIÓN – THERMO KING

12
NUEVA LEY AGRARIA: IMPULSO A LA INVERSIÓN Y COMPETITIVIDAD EN LA AGROINDUSTRIA PERUANA

56
“EN ESTE RUBRO LO MÁS IMPORTANTE ES SABER ESCUCHAR AL CLIENTE”



60
INNOVACIÓN Y TRANSPARENCIA, ETIQUETAS QUE DEBE LLEVAR LA INDUSTRIA DE ALIMENTOS REFRIGERADOS Y SALUDABLES

74
PERÚ REFUERZA LA REGULACIÓN PESQUERA CON NUEVAS SANCIONES Y SIMPLIFICACIÓN ADMINISTRATIVA


76
SELF-PACKING CHEESE: NESTLÉ REVOLUCIONA EL ENVASADO CON UN ENVASE BIODEGRADABLE HECHO DE SUERO DE QUESO

54
INNOVACIÓN ESPAÑOLA COMBATE EL DESPERDICIO ALIMENTARIO CON ETIQUETAS INTELIGENTES

66
DEL CONTROL MANUAL A LA AUTOMATIZACIÓN AVANZADA: EL NUEVO ESTÁNDAR EN PROCESAMIENTO DE ALIMENTOS
62
EN COLOMBIA




INACAL APRUEBA NUEVAS NORMAS TÉCNICAS PARA SECTORES CLAVE
El Instituto Nacional de Calidad (INACAL) ha aprobado 18 nuevas Normas Técnicas Peruanas (NTP) mediante la Resolución Directoral N° 010-2025-INACAL/DN, orientadas a fortalecer la calidad y competitividad en sectores estratégicos como agroindustria, alimentos, agua, cosmética, construcción, automotriz, textil y farmacéutico.
Entre las normas destacadas se encuentran:
NTP 011.462:2025: Requisitos de calidad para el grano blanco de quinua destinado a comercialización como materia prima.
NTP 205.061:2025: Especificaciones para hojuelas de quinua cruda destinadas al consumo humano.
NTP 208.033:2025: Método para determinar la composición de ácidos grasos en manteca de cacao mediante cromatografía de gases
NTP 202.136:2025: Procedimiento de muestreo y métodos de ensayo para determinar componentes en leche condensada azucarada.
NTP 201.003:2024/CT 1:2025: Requisitos y clasificación de carcasas y cortes de carne de porcino para consumo humano y procesamiento industrial.

PANCITOS DEL SUR PLANEA TRIPLICAR SU FACTURACIÓN CON UNA EXPANSIÓN ESTRATÉGICA
La empresa peruana busca triplicar sus ventas e internacionalizar sus productos con nuevas inversiones y mejoras tecnológicas.
Pancitos del Sur, empresa peruana de pan artesanal congelado, ha experimentado un crecimiento significativo desde su fundación en plena pandemia. En los últimos tres años, la compañía duplicó su tamaño entre 2022 y 2023 y registró un incremento adicional del 40% en 2024. Actualmente, produce entre 2,500 y 3,000 panes diarios, utilizando hasta 15 sacos de harina por semana, en comparación con los 300 panes semanales iniciales. Para alcanzar su objetivo de triplicar los ingresos y superar el millón de dólares en ventas, la empresa planea invertir entre US$40,000 y US$50,000 en infraestructura, incluyendo una nueva cámara de congelados y equipos automatizados de procesamiento. Además, se enfocará en la expansión del canal moderno, que representa el 80% de sus ventas, y en la internacionalización, con Chile y Estados Unidos como mercados prioritarios. La compañía busca financiamiento para adaptar sus productos a los requisitos técnicos y regulatorios internacionales, como los de la FDA y el SAG.
Fuente: Diario Gestión




SUSHI SOSTENIBLE: INNOVACIÓN Y TRADICIÓN EN UN FUTURO RESPONSABLE
El consumidor consciente está impulsando una transformación en el sushi. El Día Internacional del Sushi, celebrado el 18 de junio, destaca la popularidad de este platillo globalmente, pero también revela los desafíos ambientales asociados, como la sobrepesca de atún rojo y el uso excesivo de plásticos. Aunque es considerado saludable, el sushi tiene una huella ambiental significativa debido a la sobrepesca, el uso de empaques plásticos y la cadena de frío intensiva en energía. Según estudios, más del 60% del atún consumido globalmente no proviene de pesquerías sostenibles, y el sushi para llevar genera miles de toneladas de residuos plásticos anuales. Frente a estos problemas, la industria está adoptando materiales compostables, reciclables y de base biológica para reducir el impacto ambiental, mientras mantiene la calidad y seguridad del producto. La presión para encontrar soluciones sostenibles crece, sin comprometer el valor del sushi, lo que impulsa la innovación en la cadena de suministro y el diseño de empaques.
Fuente: The Food Tech

PERÚ SE CONSOLIDA COMO TERCER MAYOR PROVEEDOR DE FRUTAS DE LA UNIÓN EUROPEA
La agricultura y la alimentación son pilares esenciales en el estilo de vida peruano, y hoy Perú se destaca por abastecer al mundo con productos agrícolas de alta calidad, según Oliver Coupleux, jefe de la Sección Económica Comercial de la Unión Europea en Perú. Desde la implementación del acuerdo comercial entre Perú y la UE hace más de una década, las exportaciones agrícolas peruanas han experimentado un notable crecimiento, pasando de representar el 18% de las exportaciones a la UE en ese entonces, al 38% en 2024.
La Unión Europea se ha consolidado como el segundo mayor mercado para las agroexportaciones peruanas, alcanzando los 3.767 millones de euros en 2024, con productos clave como palta, arándano, café, cacao, uva, mango y espárrago. Este auge ha llevado a Perú a convertirse en el tercer mayor proveedor de frutas a la UE, con el 9% del total de frutas importadas, y el cuarto mayor proveedor de productos orgánicos, destacándose en banano, café, palta, kion, cacao y quinua. Además, Perú lidera como el mayor proveedor de paltas y arándanos, y es el segundo mayor exportador de uvas hacia la Unión Europea.
Fuente: Agencia Agraria de Noticias




DESCUBRE EL 'ALIMENCIONARIO': LA GUÍA DIGITAL PARA ENTENDER TODO SOBRE ALIMENTACIÓN
La FIAB lanza el "Alimencionario", un diccionario digital que ofrece información clara y actualizada sobre alimentación y nutrición.
Con el objetivo de proporcionar información clara y accesible sobre la alimentación y la nutrición, la Federación Española de Industrias de Alimentación y Bebidas (FIAB) ha lanzado el "Alimencionario", un diccionario digital diseñado para ofrecer datos responsables y útiles sobre los alimentos y sus procesos. En el marco del Día Mundial de las Redes Sociales, esta herramienta pretende ser una fuente confiable de conocimiento para el público, cubriendo desde la elaboración de los productos hasta los detalles presentes en sus etiquetas. El diccionario está concebido como un "documento vivo" que se ampliará y actualizará constantemente, garantizando que los consumidores siempre tengan acceso a contenidos actualizados y verificados sobre la industria alimentaria. Las definiciones de los términos incluyen enfoques multidisciplinarios, con base en fuentes científicas y confiables, que permiten una comprensión más completa de conceptos fundamentales como aditivos, edulcorantes, biodisponibilidad, lactosa, entre otros.
Fuente: Efe Agro
LA NARINGENINA REVOLUCIONA LA INDUSTRIA AL SER AUTORIZADA COMO MODIFICADOR DEL SABOR
Esta incorporación de la naringenina le permite ser utilizada oficialmente como modificador del sabor en productos alimentarios.
Después de más de ocho años de un exhaustivo proceso regulatorio, la Comisión Europea ha autorizado oficialmente el uso de la naringenina como modificador del sabor en productos alimentarios, una decisión formalizada a través del Reglamento (UE) 2025/1238. Este flavonoide, presente de forma natural en frutas cítricas como el pomelo, ha despertado un creciente interés en la industria por sus propiedades organolépticas y su potencial en la reformulación de bebidas con menos azúcar. Su evaluación comenzó en 2017 por la Autoridad Europea de Seguridad Alimentaria (EFSA), que en 2019 concluyó que no representaba riesgos para la salud en las dosis propuestas. La inclusión de la naringenina como “modificador del sabor” exigió una evaluación adicional bajo el Reglamento (CE) 1334/2008 sobre aromas alimentarios, y su reciente aprobación la categoriza como una sustancia aromatizante funcional bajo el código FL No. 16.133, capaz de mejorar la percepción de otros sabores sin aportar un aroma propio.
Fuente: The Food Tech


Saneamiento InnovaPack HorecaHub Alimentaria
FERIA DE SOLUCIONES Y TECNOLOGÍAS PARA PLANTAS, ESTABLECIMIENTOS Y NEGOCIOS 2025
Feria de Innovación y Tecnologías Alimentarias para la Región Andina
FoodTech Ingredients 2025
¡Este 17, 18 y 19 de julio tiene un cita con la Innovación y Tecnología alimentaria!
En su 7ma edición, la FoodTech Ingredients presenta como siempre la principal propuesta en Innovación y Tecnologías para Plantas Alimentarias, Establecimientos Horeca, Retail, Food Service, Panaderías, Pastelerías, Heladerías y Negocios Alimentarios en general.
Del 17 al 19 de julio del 2025 se llevará a cabo la 7ª edición de FoodTech Ingredients, una de las principales ferias de innovación y tecnología alimentaria en la Región Andina.
Este evento se celebrará en el Centro de Exposiciones Jockey en Lima y reunirá a los líderes del sector Alimentario, Bebidas, Agroindustria, Logística, Pesqueras, Avicolas, Carnicas, Consumo Masivo, Canal Horeca, Retail, FoodService y afines.
Plataforma de negocios y soluciones para la industria
FoodTech Ingredients 2025 se posiciona como el evento foodtech de alto valor para empresarios, gerentes, jefes y profesionales de la Industria Alimentaria, Canal Horeca y Retail que buscan soluciones para sus proyectos de inversión,
desarrollo de productos, optimizar procesos y encontrar tecnologías para sus fábricas, establecimientos y negocios alimentarios desde la producción hasta la distribución, incluyendo sectores como:
● Alimentos y Bebidas
● Ingredientes y Nutrientes
● Productos para Panadería, Pastelería, Heladería y Chocolatería
● Maquinaria, Equipos, Tecnologías y Automatización.
● Envases y Embalajes
● Higiene, Desinfección y Saneamiento
● Refrigeración comercial e industrial
● Servicios: Operadores Logísticos, Maquila, Certificación y Consultoría, Soluciones de Softwares, etc.
Con 200 empresas expositoras y más de 15 000 visitantes esperados, esta feria se centrará en mostrar lo último en avances tecnológicos y tendencias emergentes del sector industrial, ofreciendo una plataforma ideal para fortalecer alianzas y promover negocios. Actividades destacadas
A lo largo de tres días de actividades, los asistentes podrán disfrutar de diversas experiencias:
● 3 Congresos Internacionales (Ingredientes y Aditivos, Higiene y Saneamiento, y Maquinarias y Equipos)
● Rueda de Negocios Premium & Salón VIP
● II Tasting Theatre
● Salón Culinario
● III Concurso de Innovación de Alimentos y Bebidas - Innova Foods 2025

La innovación y tecnología para la industria alimentaria, Horeca, Retail y Food Service ya está AQUÍ
● I Campeonato de Pastelería Fina y Experto en Chantilly
Acerca de FoodTech Ingredients
Es organizado por Food & Health Consulting S.A.C. en colaboración con la agencia Conexión, respaldados por más de 20 años de experiencia conectando a proveedores y clientes de la Industria Alimentaria, Canal Horeca y Retail.
FoodTech Ingredients 2025 no tiene competencia, y se posiciona como la feria más importante de innovación y tecnología alimentaria en la Región Andina.
Ofreciendo un espacio para la promoción, captación de clientes, capacitación, networking y alianzas estratégicas para la expansión empresarial.
VISÍTA LA FERIA ESTE 17, 18 Y 19 DE JULIO EN EL CENTRO DE EXPOSICIONES JOCKEY:
Adquiera su entrada en: https://www.expoingredients.com/ entradas-2025
Más información en: www.expoingredients.com o www.expofoodtech.org
Celular: +51 933217230

Peruanas para fortalecer la calidad en sectores productivos clave
El Instituto Nacional de Calidad (INACAL) ha aprobado diez nuevas Normas Técnicas Peruanas (NTP) que fortalecen la competitividad y la sostenibilidad de sectores productivos fundamentales en el país, tales como la agroindustria, la seguridad laboral y la infraestructura.

Figura 1. INACAL ha aprobado diez nuevas NTP que abarcan sectores clave como la agroindustria, la seguridad laboral y la infraestructura.
"CADA NORMA SE HA APROBADO TRAS UN PROCESO DE CONSULTA PÚBLICA, LO QUE HA PERMITIDO LA PARTICIPACIÓN ACTIVA DE DIVERSOS ACTORES DE LA INDUSTRIA, ASEGURANDO QUE LAS REGULACIONES RESPONDAN A LAS NECESIDADES Y RETOS DEL SECTOR".
Acontinuación, se detallan las principales normas aprobadas:
1. NTP 209.701:2025 – "Requisitos para el control de la calidad de los alimentos procesados". Establece procedimientos para asegurar que los alimentos procesados en Perú cumplan con los estándares de inocuidad y calidad exigidos tanto a nivel nacional como internacional.
2. NTP 209.702:2025 – "Control de calidad en la producción de productos lácteos". Asegura que los productos cumplan con los requisitos de higiene y calidad, optimizando su competitividad en el mercado global.
3. NTP 334.004:2025 – "Normas para la fabricación de envases de plástico reciclado". Fomenta el uso de materiales reciclados en la industria del embalaje, alineándose con las crecientes exigencias de sostenibilidad y economía circular.
4. NTP 399.019:2025 – "Requisitos para el etiquetado de productos alimenticios". Asegura que los productos alimenticios estén correctamente etiquetados, proporcionando información clara y detallada para el consumidor y cumpliendo con las regulaciones nacionales e internacionales.
5. NTP 500.010:2025 – "Requisitos para la gestión de residuos industriales". Regula las mejores prácticas para el manejo y disposición de residuos industriales, ayu-
dando a las empresas a reducir su impacto ambiental.
6. NTP 600.005:2025 – "Certificación de servicios en la industria hotelera". Regula la calidad de los servicios ofrecidos en el sector hotelero, promoviendo un estándar de excelencia que beneficia tanto a los turistas como a los prestadores de servicios.
7. NTP 700.009:2025 – "Requisitos para la seguridad alimentaria en restaurantes". Proporciona directrices para asegurar que los restaurantes ofrezcan alimentos seguros, protegiendo la salud pública y mejorando la calidad en el sector gastronómico.
8. NTP 400.017:2025 – "Normas para el diseño y ejecución de proyectos de infraestructura urbana". Fija los lineamientos técnicos para la ejecución de proyectos de infraestructura en áreas urbanas.
9. NTP 100.008:2025 – "Requisitos para la fabricación de productos textiles sostenibles". Establece los parámetros para la producción de textiles con materiales que respeten el medio ambiente.
10.NTP 800.015:2025 – "Normas de seguridad en la fabricación de productos electrónicos". Regula las condiciones de seguridad y calidad en la fabricación de dispositivos electrónicos.
Fuente: gob.pe



























la
La reciente aprobación en primera votación de la nueva Ley Agraria busca revitalizar el sector agroindustrial peruano mediante incentivos tributarios y la integración de pequeños productores a cadenas de valor exportadoras.

Figura 1. Esta normativa tiene como objetivo impulsar la competitividad del agro peruano mediante incentivos tributarios y políticas de inclusión, especialmente dirigidas a los pequeños productores.
"LA NUEVA LEY AGRARIA PROPONE UNA REDUCCIÓN DEL IMPUESTO A LA RENTA AL 15% PARA EMPRESAS AGROEXPORTADORAS Y BUSCA INTEGRAR A PEQUEÑOS PRODUCTORES EN LAS CADENAS DE VALOR AGROINDUSTRIALES, CON EL OBJETIVO DE REACTIVAR LA INVERSIÓN Y FORTALECER LA COMPETITIVIDAD DEL SECTOR".
El 9 de junio de 2025, el Congreso del Perú aprobó en primera votación el proyecto de la nueva Ley Agraria, un paso importante para reactivar y fortalecer el sector agroindustrial del país. Esta normativa, que ha sido cuidadosamente elaborada por un grupo de expertos del sector, tiene como objetivo impulsar la competitividad del agro peruano mediante incentivos tributarios y políticas de inclusión, especialmente dirigidas a los pequeños productores. En este contexto, la ley se presenta como una herramienta clave para mejorar la eficiencia del sector y aumentar la inversión extranjera y nacional, esenciales para la sostenibilidad de la agroindustria.
Una de las medidas más destacadas que ofrece la nueva ley es la reducción del Impuesto a la Renta (IR) para las empresas agroexportadoras, que pasará del 29.5% al 15% durante el periodo 2025-2035. Este ajuste fiscal busca hacer más atractiva la inversión en el sector,
promoviendo la modernización de las infraestructuras productivas, la mejora de la tecnología en el campo y la ampliación de los mercados internacionales para los productos peruanos. Esta reforma tributaria también tiene como objetivo reducir la incertidumbre que ha afectado a las empresas agroexportadoras en los últimos años, fomentando un clima de confianza y previsibilidad que impulse el flujo de capitales hacia el país.
El impacto esperado de esta medida es considerable, especialmente en un momento en el que el sector agroindustrial ha sufrido una desaceleración en sus niveles de inversión. Según el exministro de Economía, Ismael Benavides, en el periodo 2020-2024 se dejaron de invertir alrededor de US$ 3.500 millones en el agro moderno, y entre 25.000 y 30.000 hectáreas de tierras productivas fueron abandonadas. La baja de la inversión privada ha sido uno de los factores que ha frenado el crecimiento del sector,
a pesar de su potencial. La nueva ley busca revertir esta situación y poner al Perú en una posición más competitiva frente a otros países productores.
Además de la reducción de impuestos, la nueva ley también incluye medidas que buscan integrar a los pequeños productores en las cadenas de valor agroindustriales. El 80% de la producción de palta destinada a la exportación, por ejemplo, proviene de la agricultura familiar y de pequeños agricultores. Esta fórmula ha demostrado ser efectiva, y el objetivo es replicarla en otros cultivos clave, como el mango, el cacao y los arándanos. La ley propone políticas de fomento y asistencia técnica para que estos productores puedan acceder a mejores tecnologías, mejorar sus capacidades productivas y aumentar su presencia en los mercados internacionales.
La formalización del sector agroindustrial también es una prioridad dentro de esta nueva legislación. A través de esta ley, se busca dar un paso firme hacia la modernización del campo, incentivando la formalización de los pequeños productores mediante el acceso a beneficios fiscales y al financiamiento adecuado.
Un aspecto fundamental de la nueva ley es su potencial para generar empleo en las regiones rurales. Según los datos del Instituto Nacional de Estadística e Informática (INEI), en regiones como Ica, la pobreza ha disminuido significativamente, alcanzando niveles del 5%, y el desempleo es prácticamente nulo, gracias a la agroindustria. En estas zonas, el empleo en el sector agroexportador ha permitido mejorar las condiciones de vida de miles de familias, especialmente a través de la agricultura de productos como las uvas, las paltas y los arándanos. Además, la agroindustria ha atraído a migrantes de diversas regiones del país, como Huancave-
lica, Ayacucho y Cusco, quienes han encontrado nuevas oportunidades laborales en el sector.
Este modelo de desarrollo inclusivo es crucial para lograr una expansión sostenida y equilibrada de la agroindustria, contribuyendo a la reducción de la pobreza en las zonas rurales. Según los expertos, una mayor inversión en infraestructura, tecnología y capacitación permitirá elevar la competitividad del sector agroindustrial, tanto a nivel nacional como internacional. De acuerdo con Mario Salazar, presidente del Comité de Agroindustrias, Alimentos y Bebidas de ADEX, la ley permitirá posicionar al Perú como un líder en la producción y exportación de alimentos saludables y sostenibles, garantizando que sus productos cumplan con los estándares ambientales más altos.
La ley fomentará el uso de tecnologías limpias, la gestión eficiente del agua y la reducción de las emisiones de gases de efecto invernadero, para asegurar que los productos peruanos puedan competir en un mercado global cada vez más exigente.
Cabe resaltar que la nueva Ley Agraria aún debe ser aprobada en segunda votación por el Congreso para su promulgación definitiva. En este sentido, los actores del sector agroindustrial, tanto públicos como privados, han expresado su apoyo a la norma, aunque también han señalado que es necesario continuar trabajando en su implementación para garantizar que las medidas propuestas lleguen a todos los productores, especialmente a aquellos más pequeños y vulnerables.
"A TRAVÉS DE ESTA LEY, SE BUSCA DAR UN PASO FIRME HACIA LA MODERNIZACIÓN DEL CAMPO, INCENTIVANDO LA FORMALIZACIÓN DE LOS PEQUEÑOS PRODUCTORES MEDIANTE EL ACCESO A BENEFICIOS FISCALES Y
AL FINANCIAMIENTO ADECUADO".


Las exportaciones de uvas frescas peruanas alcanzaron los US$ 742 millones, representando un crecimiento del 56% en comparación con el mismo periodo del año anterior, consolidándose como el principal producto agroexportador del país.
Fuente: Diario Correo

Perú se consolida como líder agroindustrial: Noveno mayor proveedor de EE.UU
Perú ocupó el noveno lugar entre los principales proveedores de productos agroindustriales a Estados Unidos en 2024, con una participación del 2% en las exportaciones totales de este sector, según informó la Asociación de Exportadores (Adex).

Perú consolidó su posición como uno de los principales proveedores de productos agroindustriales a Estados Unidos, un mercado que importó bienes por un total de 221,800 millones de dólares. El país ocupó el noveno lugar en este ranking, compitiendo directamente con países como México, que lideró con 49,800 millones de dólares (25% del total), Canadá con 42,000 millones, la Unión Europea con 34,400 millones, Brasil con 8,400 millones y China con 6,600 millones.
til-confecciones sumaron 118,400 millones de dólares, con China, Vietnam e India como principales proveedores. Perú ocupó el puesto 21 a nivel global, representando el 8.8% del total. Asimismo, EE.UU. adquirió productos específicos como suéteres y t-shirts de algodón.
Sector pesquero
"EL MERCADO PERUANO REFUERZA
Adex señaló que Perú compite con estos países en una amplia gama de productos agroindustriales. Con México, la competencia se da en categorías como paltas, capsicum, limones, mangos, uvas, arándanos y chocolates. Con Canadá, la rivalidad incluye chocolates, galletas dulces, café tostado, capsicum y arándanos, mientras que con la Unión Europea, Perú se enfrenta en mercados de aceitunas, galletas dulces, cacao en polvo, café tostado, cebollas y otros productos.
Industria textil
El año pasado, las importaciones de Estados Unidos en la cadena tex-
Las importaciones globales de productos pesqueros de Estados Unidos, tanto tradicionales como no tradicionales, sumaron 28,079 millones de dólares el año pasado. Perú, con 355 millones de dólares en exportaciones, se ubicó como su 15° proveedor, siendo superado por otros países de la región como Chile, Ecuador, México, Argentina y Brasil. Entre los productos pesqueros más demandados destacan el aceite refinado de pescado y los filetes de perico congelado.
Según el Centro de Investigación de Economía y Negocios Globales de Adex, se estima que el 78% del valor exportado por Perú a EE.UU. (7,430 millones de dólares de un total de 9,528 millones) podría estar en riesgo debido al aumento de los aranceles al 10%.
Fuente: Andina






Una dieta vegana baja en grasas reduce significativamente la carga ácida en el organismo y favorece la pérdida de peso, según un estudio del Comité de Médicos por una Medicina Responsable.

El consumo de alimentos ácidos, como carnes, huevos y lácteos, puede aumentar la carga ácida en la dieta, lo que favorece la inflamación y el aumento de peso. En cambio, sustituir estos productos de origen animal por opciones vegetales, como verduras de hoja verde, bayas y legumbres, podría ayudar a promover la pérdida de peso y mejorar el microbioma intestinal.
indicadores: Carga ácida renal potencial (PRAL) y Producción neta de ácidos endógenos (NEAP). Los resultados mostraron que los productos de origen animal, como la carne y los lácteos, incrementan la carga ácida en la dieta, lo cual está asociado con inflamación crónica y alteraciones metabólicas.
"UNA DIETA VEGETAL,
GRASAS
Este hallazgo proviene de una investigación publicada en la revista Frontiers in Nutrition, que analizó el impacto de dos tipos de dietas en adultos con sobrepeso. El estudio, realizado con 62 participantes, comparó una dieta mediterránea con una dieta vegana baja en grasas durante 16 semanas, con un período de limpieza de cuatro semanas en el medio. Posteriormente, los participantes fueron asignados a la dieta contraria, permitiendo una comparación más clara de los efectos.
PESO".
Para evaluar los efectos de las dietas, los investigadores calcularon la carga ácida de los alimentos consumidos por los participantes utilizando dos
Por el contrario, las dietas basadas en plantas, al ser más alcalinas, se asociaron con efectos beneficiosos, como la pérdida de peso, la mejora de la sensibilidad a la insulina y una reducción de la presión arterial. Este tipo de alimentación se ha vinculado a un perfil más saludable en términos metabólicos, lo que la convierte en una opción viable para quienes buscan perder peso de forma sostenible. El estudio mostró que la dieta vegana redujo significativamente las puntuaciones de PRAL y NEAP, lo que indica una menor carga ácida. Los participantes que siguieron esta dieta perdieron un promedio de 6 kilos, mientras que los de la dieta mediterránea no experimentaron cambios en su peso.
Fuente: Infosalus

19 alimentos antiinflamatorios recomendados por expertos para una dieta saludable
Incorporar alimentos con propiedades antiinflamatorias puede ser clave para prevenir enfermedades crónicas y mejorar el bienestar general.
La inflamación es una respuesta natural del cuerpo ante infecciones o lesiones, pero cuando se vuelve crónica, puede contribuir al desarrollo de enfermedades como diabetes tipo 2, enfermedades cardiovasculares y ciertos tipos de cáncer. Una dieta rica en alimentos con propiedades antiinflamatorias puede ayudar a reducir este riesgo y promover una mejor salud.
Según expertos en nutrición, algunos alimentos destacan por sus propiedades antiinflamatorias. Las frutas rojas y bayas, como frutillas, arándanos, frambuesas y moras, son ricas en antocianinas, antioxidantes que pueden reducir los marcadores de inflamación. Se recomienda variar su consumo para aprovechar sus beneficios.
Las verduras de hoja verde, como espinacas, col, brócoli y acelgas, aportan vitaminas A, C y K, además de magnesio, nutrientes que favorecen la protección celular. Su inclusión regular en la dieta puede ser beneficiosa para la salud.
Los pescados grasos, como salmón, caballa, sardinas y atún, contienen ácidos grasos omega-3, que pueden disminuir moléculas proinflamatorias. Los expertos sugieren consumirlos al menos dos veces por semana.
Frutos secos y semillas, como nueces, almendras, semillas de chía y de lino, ofrecen grasas saludables, fibra y antioxidantes. Se recomienda un puñado diario para obtener sus beneficios El aceite de oliva extra virgen, rico en polifenoles y grasas monoinsaturadas, es un componente clave de la dieta mediterránea y se asocia con propiedades antiinflamatorias.
Los tomates contienen licopeno, un antioxidante que ayuda a combatir la inflamación. Cocinarlos junto a una fuente de grasa saludable mejora su absorción. La cúrcuma, gracias a la curcumina, y el jengibre, con propiedades que favorecen la reducción de la inflamación y mejoran la digestión, son especias que pueden incorporarse en diversas preparaciones para potenciar sus efectos beneficiosos.
Las legumbres, como lentejas, garbanzos y frijoles, aportan fibra, proteína vegetal y antioxidantes, contribuyendo a la salud intestinal y reduciendo la inflamación. El té verde, rico en catequinas, es una bebida que puede consumirse para aprovechar sus propiedades antiinflamatorias.
Fuente: Infobae

Figura 1. Las frutas rojas y bayas, como los arándanos, fresas y moras, contienen antocianinas que ayudan a reducir la inflamación y proteger las células del daño oxidativo.
"EL
ACEITE DE OLIVA EXTRA VIRGEN, RICO EN POLIFENOLES Y GRASAS MONOINSATURADAS, ES UN COMPONENTE CLAVE DE LA DIETA MEDITERRÁNEA Y SE ASOCIA CON PROPIEDADES ANTIINFLAMATORIAS".

Incorporar proteínas completas en la dieta diaria es esencial para prevenir la pérdida de masa muscular y mantener la salud general en adultos mayores.

Figura 1. El yogur, los huevos y el pescado en conserva son fuentes de proteína de alta calidad que pueden incorporarse fácilmente en la dieta diaria de personas mayores de 50 años para mantener la salud muscular y general.
"SEGÚN LA ORGANIZACIÓN
MUNDIAL DE LA SALUD Y LA FAO, UNA DIETA CON SUFICIENTE PROTEÍNA DE ALTO
VALOR BIOLÓGICO ES FUNDAMENTAL
PARA MANTENER LA FUNCIONALIDAD FÍSICA EN ADULTOS MAYORES".
Amedida que se avanza en edad, la ingesta adecuada de proteínas de alta calidad se vuelve crucial para preservar la masa muscular y prevenir la sarcopenia, una condición caracterizada por la pérdida progresiva de masa muscular esquelética. Según la Organización Mundial de la Salud y la FAO, una dieta con suficiente proteína de alto valor biológico es fundamental para mantener la funcionalidad física en adultos mayores. Para facilitar la incorporación de proteínas completas en la dieta diaria, se destacan tres fuentes accesibles y nutritivas:
1. Yogur natural o tipo griego: Es una excelente fuente de proteínas completas y calcio. Su versatilidad permite integrarlo en desayunos, meriendas o como postre saludable, combinado con frutas o frutos secos. Además de contribuir a la síntesis muscular, el calcio que aporta es clave para mantener la densidad ósea y prevenir la osteoporosis, una preocupación frecuente en esta etapa de la vida.
2. Huevos: Reconocidos por su contenido en proteínas de alto valor biológico, los huevos son una opción económica y fácil de preparar. Un huevo contiene aproximadamente seis gramos de proteína y aporta nutrientes esenciales como vitamina B12, riboflavina y vita-
mina D. Su preparación sencilla, desde cocidos hasta revueltos o en tortilla, facilita su inclusión regular en la dieta.
3. Pescado en conserva: Sardinas, atún y caballa enlatados constituyen una fuente práctica de proteína y ácidos grasos omega-3, que favorecen la salud cardiovascular y cerebral. Este tipo de pescado es ideal para quienes buscan soluciones rápidas sin sacrificar valor nutricional. Su conservación permite mantenerlos disponibles en la despensa y utilizarlos en ensaladas, bocadillos o platos principales.
Incorporar estas fuentes de proteína en las comidas diarias puede ser una estrategia efectiva para mantener la salud muscular y general en adultos mayores. Se recomienda consumir entre 1,2 y 1,6 gramos de proteína por kilogramo de peso corporal al día, distribuidos en las diferentes comidas, para optimizar la síntesis de proteínas musculares.
Además de una ingesta adecuada de proteínas, es esencial mantener una dieta equilibrada que incluya una variedad de nutrientes, realizar actividad física regular y consultar con profesionales de la salud para adaptar las recomendaciones a las necesidades individuales.
Fuente: La Nación


DIGESA brinda precisión sobre declaración en rotulado de productos que contienen tartrazina
El Ministerio de Salud (MINSA), a través de la Dirección General de Salud Ambiental e Inocuidad AlimentariaDIGESA, comunica a empresas fabricantes de alimentos elaborados industrialmente que emplean el aditivo Tartrazina SIN 102 lo siguiente:
DIRECCIÓN GENERAL DE SALUD AMBIENTAL
Figura 1. El DIGESA establece nueva obligación de rotulado para productos con tartrazina, garantizando información clara y segura para los consumidores.
"LA ORGANIZACIÓN MUNDIAL DE LA SALUD (OMS) Y LA FAO HAN ESTABLECIDO LÍMITES
SEGUROS PARA SU CONSUMO, PERO LA VARIABILIDAD EN LA SENSIBILIDAD DE LOS INDIVIDUOS HACE
QUE UNA MAYOR TRANSPARENCIA EN LA INFORMACIÓN SEA ESENCIAL".
1. En el marco de la sentencia expedida por el Décimo Juzgado Constitucional de la Corte Superior de Justicia de Lima (expediente N° 08388-2013-0-1801-JR-CI-10, confirmada mediante Resolución N° 07 del 17 de julio de 2020 por la Tercera Sala Civil de la Corte Superior de Justicia de Lima), todo producto que emplee el aditivo en mención debe declarar en el rotulado, al final de la lista de ingredientes; en forma específica, destacada, clara, visible e indubitable, con letra mayúscula y negrita: “CONTIENE TARTRAZINA” y adicionar la siguiente frase; “uso recomendable de hasta 7.5 mg/kg peso/día”.
2. Es importante mencionar que, se otorga el tiempo máximo de 365 días calendarios (01 año), contados a partir de la emisión del presente comunicado, para el agotamiento de stock de las etiquetas (rotulado) que no contengan esta declaración.
3. Finalmente, se exhorta a las empresas fabricantes empezar a sustituir paulatinamente el aditivo por otros aditivos que se encuentren previstos en el Codex Alimentarius para la categoría de alimentos correspondiente, priorizando los alimentos destinados a los niños y las niñas, lo cual deben tramitarse mediante el Texto Único de Procedimientos Administrativos- TUPA 31.
Esta medida busca reforzar la protección de la salud pública, especialmente en consumidores vulnerables como los niños, que son más susceptibles a los posibles efectos adversos de la tartrazina. Se sabe que este aditivo, si bien aprobado por organismos internacionales como el Codex Alimentarius, ha estado bajo escrutinio debido a estudios que sugieren que podría inducir reacciones alérgicas y afectar el comportamiento, como el aumento de hiperactividad en niños. Por ello, la implementación de este etiquetado más claro es fundamental para que los consumidores puedan tomar decisiones informadas sobre los productos que adquieren.
Además, organismos como la Organización Mundial de la Salud (OMS) y la FAO han establecido límites seguros para su consumo, pero la variabilidad en la sensibilidad de los individuos hace que una mayor transparencia en la información sea esencial. Este esfuerzo también responde a una creciente tendencia hacia el consumo de productos más naturales y menos procesados, lo que podría llevar a las empresas a considerar alternativas más seguras para reemplazar la tartrazina, como el uso de colorantes naturales derivados de plantas.
Fuente: Ministerio de Salud (MINSA)

Cursos, talleres, congresos o seminarios GRATUITOS
Cursos especializados asincrónicos GRATUITOS.


Bono 40% Dscto. en cursos adicionales que desee al año.
Revistas Industria Alimentaria impresas, GRATIS a domicilio.



DESCUENTO PRE-VENTA 2025


La Unión Europea ha actualizado su legislación en materia de importaciones de productos lácteos y aditivos alimentarios, exigiendo nuevas certificaciones sanitarias y listas específicas de establecimientos para fortalecer la seguridad alimentaria.

1. El Reglamento Delegado (UE) 2025/637 establece que los productos lácteos y aditivos de origen animal deben contar con certificados sanitarios oficiales para ingresar a la Unión Europea.
"EL NUEVO
REGLAMENTO
QUE LOS PRODUCTOS LÁCTEOS Y ADITIVOS DE ORIGEN ANIMAL DEBEN CONTAR CON CERTIFICADOS SANITARIOS OFICIALES PARA INGRESAR A LA UE".
El 29 de enero de 2025, la Comisión Europea adoptó el Reglamento Delegado (UE) 2025/637, con el objetivo de reforzar la seguridad alimentaria y garantizar la trazabilidad de los productos de origen animal importados a la Unión Europea. Esta actualización modifica el Reglamento Delegado (UE) 2022/2292, introduciendo nuevas exigencias para una serie de productos clave en la industria alimentaria.
Productos afectados
Los productos que se ven directamente impactados por esta modificación incluyen:
● Productos lácteos y derivados.
● Aditivos alimentarios obtenidos a partir de animales.
● Tripas de colágeno.
● Carne picada y preparados de carne.
● Carne separada mecánicamente.
● Productos compuestos que contengan cápsulas de gelatina.
Requisitos para la importación
Conforme a la normativa actualizada, se establecen los siguientes requisi-
tos para la entrada de estos productos en la Unión Europea:
1. Lista de terceros países autorizados: Solo se permitirá la importación de productos de origen animal procedentes de terceros países que figuren en una lista específica elaborada conforme al artículo 11 del Reglamento (CE) n.º 854/2004. Esta lista debe ser actualizada periódicamente para garantizar que los países exportadores mantengan estándares equivalentes a los de la UE en materia de seguridad alimentaria.
2. Establecimientos aprobados: Los productos deben provenir de establecimientos que estén incluidos en una lista de establecimientos autorizados, elaborada de acuerdo con el artículo 127 del Reglamento (UE) 2017/625. Estos establecimientos deben cumplir con los requisitos de higiene y control establecidos por la legislación comunitaria.
3. Certificación sanitaria:
Cada partida de productos debe ir acompañada de un certifica-
do sanitario oficial que garantice que el producto cumple con los requisitos de seguridad alimentaria establecidos por la legislación de la UE. Este certificado debe ser expedido por las autoridades competentes del país de origen y debe acompañar a la mercancía durante todo el proceso de importación.
4. Exámenes y controles adicionales:
Dependiendo del tipo de producto, pueden ser requeridos exámenes adicionales o inspecciones de laboratorio para garantizar que los productos cumplen con las normativas de seguridad alimentaria antes de ser aprobados para su ingreso a la UE. Estas pruebas pueden incluir análisis microbiológicos y la verificación de la ausencia de residuos de productos químicos o antibióticos.
Impacto en la industria alimentaria
La implementación de estos requisitos tiene un impacto significativo en la industria alimentaria, especialmente en los sectores de la agroindustria y la producción de ingredientes alimentarios. Las empresas exportadoras deberán asegurarse de que sus productos cumplan con las normativas establecidas, lo que puede implicar inversiones en infraestructura, formación y sistemas de trazabilidad. Además, la necesidad de obtener certificaciones sanitarias y cumplir con los estándares de los establecimientos aprobados puede generar costos adicionales. Sin embargo, estas medidas también ofrecen oportunidades para mejorar la calidad y seguridad de los productos, lo que puede fortalecer la competitividad de las empresas en el mercado europeo.
Una de las principales ventajas de esta actualización es que garantizará una mayor transparencia en la cadena de suministro. Los consumidores de la Unión Europea podrán tener más confianza en los productos importados, sabiendo que cumplen con los más estrictos estándares sanitarios y de seguridad alimentaria.
El papel de los importadores y autoridades nacionales
Los importadores, así como las autoridades nacionales de los países exportadores, jugarán un papel crucial en la implementación de estas nuevas regulaciones. Los importadores deberán trabajar en estrecha colaboración con las autoridades competentes de los países de origen para asegurarse de que todos los requisitos estén en orden antes de que los productos lleguen a las fronteras de la UE.
A su vez, las autoridades nacionales de los países exportadores deberán asegurarse de que los establecimientos que producen estos productos estén debidamente registrados y cumplan con las normativas europeas. Este sistema de colaboración entre las partes es esencial para garantizar que los productos sean aptos para el consumo y no presenten riesgos para la salud pública.
La actualización del Reglamento Delegado (UE) 2025/637 representa un paso importante hacia el fortalecimiento de la seguridad alimentaria en la Unión Europea. Al establecer requisitos más estrictos para la importación de productos de origen animal, se busca garantizar que solo aquellos productos que cumplen con los más altos estándares de calidad y seguridad lleguen al mercado europeo. Las empresas exportadoras deberán adaptarse a estas nuevas exigencias para continuar accediendo al mercado de la UE, lo que implica un compromiso con la mejora continua y la excelencia en sus procesos productivos.
Además, esta normativa refuerza la transparencia en las cadenas de suministro de productos de origen animal, lo que genera confianza en los consumidores y potencia la competitividad de los productos europeos. La implementación efectiva de estas normas también contribuirá a la reducción de riesgos alimentarios y a la mejora de la salud pública en la región.
"LOS PRODUCTOS DE ORIGEN ANIMAL DEBEN PROVENIR DE ESTABLECIMIENTOS
AUTORIZADOS POR LA UE, LO QUE ASEGURA QUE LOS ESTÁNDARES SANITARIOS Y DE CALIDAD SEAN CUMPLIDOS DURANTE TODO EL PROCESO DE PRODUCCIÓN".

2. Con la nueva normativa, los productos de origen animal deben provenir de establecimientos autorizados por la UE, lo que asegura que los estándares sanitarios y de calidad sean cumplidos durante todo el proceso de producción.
3. La norma exige inspecciones adicionales y análisis microbiológicos para los productos de origen animal importados.
Fuente: Revista Alimentaria

Tecnología al servicio de la seguridad alimentaria en la industria cárnica
Ante los crecientes desafíos sanitarios, regulatorios y logísticos, el sector cárnico acelera la adopción de soluciones tecnológicas enfocadas en la inocuidad alimentaria. La digitalización de procesos, la trazabilidad en tiempo real y el monitoreo predictivo marcan el nuevo estándar de operación.

Figura 1. Los sensores inteligentes permiten monitorear variables críticas como temperatura, humedad y pH, reduciendo tiempos de respuesta ante desviaciones en las líneas de producción.
La industria cárnica enfrenta hoy una creciente presión por parte de consumidores, entes reguladores y clientes corporativos que exigen no solo productos de alta calidad, sino también procesos seguros, sostenibles y trazables. En este escenario, la inocuidad alimentaria deja de ser una obligación técnica para convertirse en un diferenciador estratégico. Frente a este desafío, las soluciones tecnológicas se consolidan como aliadas clave para garantizar el cumplimiento normativo, optimizar los recursos y reducir riesgos en cada eslabón de la cadena de valor.
"LA INOCUIDAD ALIMENTARIA DEJA DE SER UNA OBLIGACIÓN TÉCNICA PARA CONVERTIRSE EN UN DIFERENCIADOR ESTRATÉGICO".
Una de las áreas que más ha evolucionado es la digitalización de los sistemas de monitoreo en planta. Equipos dotados de sensores inteligentes permiten supervisar en tiempo real parámetros como temperatura, humedad, pH y contaminantes, generando alertas tempranas ante cualquier desviación del estándar. Esta información, integrada en plataformas de análisis predictivo, facilita una toma de decisiones más rápida y precisa, con enfoque preventivo.
La trazabilidad también ha dado un salto cualitativo. A través de soluciones basadas en blockchain o plataformas integradas en la nube, hoy es posible seguir cada lote desde el sacrificio hasta el punto de venta, registrando eventos críticos en tiempo real. Esto no solo asegura la transparencia frente a auditorías, sino que permite actuar con agilidad en caso de alertas sanitarias, reduciendo el impacto de posibles retiros masivos. Por su parte, el uso de inteligencia artificial y machine learning en los procesos de control de calidad ha mejorado la capacidad de predicción de riesgos microbiológicos. Algoritmos alimentados por datos históricos y ambientales pueden identificar patrones que anticipan fallos operativos o condiciones propensas a brotes bacterianos. Esta información es especialmente valiosa en líneas de producción de alto volumen, donde la detección temprana puede significar la diferencia entre un lote salvado y una pérdida millonaria.
En paralelo, los sistemas de automatización y robótica sanitaria están
reduciendo la exposición humana a puntos críticos y mejorando la estandarización de procesos. Desde brazos robotizados para cortes asépticos hasta sistemas de limpieza automatizados (CIP), estas soluciones no solo elevan la productividad, sino que refuerzan los protocolos de inocuidad y reducen el margen de error.
Otra línea de innovación que está ganando espacio es la aplicación de tecnologías de desinfección sin residuos, como el ozono gaseoso, la luz ultravioleta (UV-C) y el plasma frío. Estos métodos permiten inactivar patógenos sin añadir químicos al entorno ni dejar trazas en el producto, lo que responde a normativas más estrictas y a consumidores cada vez más atentos a la composición final de los alimentos.
No menos relevante es el factor humano. La tecnología por sí sola no garantiza resultados sostenibles si no va acompañada de una cultura
Expo
organizacional orientada a la inocuidad. Esto implica formación continua del personal, procedimientos estandarizados y auditorías internas que refuercen la mejora constante. La gestión de la seguridad alimentaria debe ser transversal y estratégica, no operativa ni reactiva.
La convergencia de estos factores ha redefinido el concepto de competitividad en la industria cárnica. Ya no basta con cumplir lo mínimo requerido; hoy se exige una trazabilidad absoluta, respuestas ágiles ante incidentes y un control riguroso sobre cada etapa del proceso. En un entorno donde los mercados internacionales elevan sus exigencias y los consumidores castigan el más mínimo error, la tecnología aplicada a la inocuidad alimentaria no es un lujo: es una inversión crítica para garantizar sostenibilidad, reputación y crecimiento a largo plazo.
Fuente: The Food Tech

2. La trazabilidad digital basada en blockchain garantiza transparencia total desde el origen del producto hasta el consumidor, fortaleciendo la seguridad alimentaria y la gestión de crisis.
"LOS SISTEMAS DE AUTOMATIZACIÓN Y ROBÓTICA SANITARIA
ESTÁN REDUCIENDO LA EXPOSICIÓN HUMANA A PUNTOS CRÍTICOS, DESDE BRAZOS ROBOTIZADOS PARA CORTES ASÉPTICOS HASTA SISTEMAS DE LIMPIEZA AUTOMATIZADOS (CIP)".
2025
Saneamiento InnovaPack HorecaHub Alimentaria
FERIA DE SOLUCIONES Y TECNOLOGÍAS PARA PLANTAS, ESTABLECIMIENTOS Y NEGOCIOS
EVENTOS ESPECIALIZADOS: 4 Congresos Internacionales
III Concurso de Innovación de Alimentos y Bebidas: Innova Foods 2025
CULINARIA: Innovación y técnica gastronómica Mesas de Negocio Premium - Tasting Theatre - Salón VIP y más
LANZAMIENTOS DE PABELLONES: Alimentaria HORECA Deco. HorecaHub
17,18,19 de Julio
· CENTRO DE EXPOSICIONES JOCKEY · Lima - Perú
www.expoingredients.com

La seguridad alimentaria es una responsabilidad colectiva que involucra a diversas autoridades y requiere la implementación del enfoque multisectorial de "Una sola salud".

Figura 1. Los alimentos orgánicos pueden ser más vulnerables a ciertas enfermedades alimentarias, ya que carecen de pesticidas que previenen la contaminación.
El acceso a alimentos inocuos y nutritivos es esencial para la salud humana, ya que los alimentos contaminados pueden causar más de 200 enfermedades, desde diarreas hasta cáncer, afectando especialmente a los más vulnerables: niños, ancianos y enfermos. La colaboración entre gobiernos, productores y consumidores es clave para garantizar la seguridad alimentaria.
Las enfermedades de origen alimentario son causadas por bacterias, virus, parásitos y sustancias químicas presentes en alimentos o agua contaminados, provocando desde intoxicaciones agudas hasta enfermedades crónicas. Entre las principales:
● Listeria: Aunque poco frecuente, su ingestión puede provocar abortos espontáneos o muerte neonatal. Se encuentra en productos lácteos no pasteurizados y alimentos listos para el consumo. Es especialmente grave para lactantes, niños y ancianos.
● Vibrio cholerae: Provoca cólicos abdominales, vómitos y diarrea líquida abundante, que puede resultar en deshidratación extrema y muerte. Los alimentos más comúnmente asociados con el cólera son las hortalizas crudas y mariscos crudos o mal cocidos.
La inocuidad alimentaria en un mundo cambiante
"LA INOCUIDAD DE LOS ALIMENTOS, LA NUTRICIÓN Y LA SEGURIDAD ALIMENTARIA ESTÁN INTERCONECTADAS, YA QUE LA CALIDAD DE LOS ALIMENTOS ES ESENCIAL PARA UNA NUTRICIÓN ADECUADA Y SALUDABLE".
● Salmonella: Se transmite principalmente por alimentos de origen animal, como huevos y carne de ave. Provoca fiebre, dolor de cabeza, náuseas, vómitos y diarrea.
● Campylobacter: Comúnmente adquirida por el consumo de carne de ave cruda o poco cocinada, leche no pasteurizada o agua contaminada. Los síntomas incluyen fiebre, dolor abdominal y diarrea.
● Escherichia coli enterohemorrágica: Transmitida por leche no pasteurizada, carne poco cocinada y frutas y verduras frescas, puede causar diarrea sanguinolenta y complicaciones graves.
La seguridad alimentaria es crucial para la salud, la economía y el desarrollo sostenible. Sin embargo, la urbanización, la globalización y el cambio climático están complicando la cadena alimentaria, aumentando los riesgos de enfermedades. Los fenómenos climáticos extremos y el cambio en los patrones de temperatura y precipitaciones pueden intensificar estos riesgos, haciendo que los incidentes locales se conviertan rápidamente en emergencias internacionales, lo que exige una mayor responsabilidad de los productores en cuanto a la inocuidad de los alimentos.
Fuente: Organización Mundial de la Salud








Lo que debes conocer sobre las nuevas normas
La ISO 22000 está siendo revisada y se espera que su actualización se publique en septiembre del próximo año.

1. Sistemas Internacionales de Gestión promueven buenas prácticas en la industria alimentaria para evitar la contaminación por bacterias, como la Listeria.
"APROXIMADAMENTE 600 MILLONES DE PERSONAS EN TODO EL MUNDO PADECEN ENFERMEDADES O SUFREN DAÑOS DEBIDO A ALIMENTOS CONTAMINADOS AL AÑO, LO QUE PONE DE MANIFIESTO LA NECESIDAD URGENTE DE ESTABLECER SISTEMAS SÓLIDOS Y CERTIFICADOS DE GESTIÓN DE INOCUIDAD ALIMENTARIA".
Es crucial estar informado en seguridad alimentaria, especialmente considerando los más de 150 incidentes de Listeria registrados en 2024. Este patógeno sigue siendo una de las principales preocupaciones, y la contaminación suele estar asociada a malas prácticas de manufactura o a una limpieza insuficiente en las instalaciones de procesamiento, más que a fallos en los Puntos de Control Críticos (PCC).
Existen diversos sistemas de gestión de inocuidad alimentaria ampliamente reconocidos, como el BRCGS, ISO, FSSC 22000 e IFS, que permiten certificar diferentes aspectos de la industria, abarcando desde productos animales y vegetales hasta envases, aditivos e incluso el diseño higiénico de las instalaciones.
Revisión de la ISO 22000
La norma ISO 22000, referente a los sistemas de gestión de la inocuidad alimentaria, está siendo revisada para actualizar sus requisitos y adaptarse a los cambios que presenta la industria. Durante este proceso, las organizaciones podrán presentar sus comentarios finales sobre los documentos en discusión. La versión final se publicará en septiembre de 2025, con traducciones disponibles en varios idiomas, incluidos español e inglés.
Aspectos clave de la revisión de la ISO
- Alineación con otros sistemas de gestión: La versión revisada de la ISO 22000 mantendrá una estructura compatible con otras normas de gestión, como la ISO 9001 (calidad) y la ISO 14001 (medio ambiente).
- Consideración del cambio climático: Las empresas deberán examinar el impacto del cambio climático en la seguridad alimentaria y el funcionamiento de sus sistemas.
- Refuerzo en el control de alérgenos y prevención del fraude alimentario: Se implementarán medidas más rigurosas para el manejo de alérgenos y la lucha contra el fraude alimentario.
- Impulso a la cultura de seguridad alimentaria: La norma fomentará un mayor énfasis en la cultura de inocuidad.
- Fomento de la reducción de pérdidas y desperdicios: Se incluirá la gestión de pérdidas y desperdicios como un requisito clave, alineando la ISO 22000 con normativas como la ISO 20000.
- Explicación sobre PRPs y CPs: En respuesta a las dudas de los participantes, se añadirá un anexo aclaratorio sobre la distinción entre los Programas de Prerrequisitos (PRPs) y los Puntos de control críticos (CPs).
Fuente: The Food Tech


















































exigencias en la fabricación de alimentos: Seguridad, higiene y eficiencia operativa
La industria alimentaria está experimentando una transformación impulsada por avances tecnológicos y la creciente demanda de prácticas más seguras y sostenibles en montaje y mantenimiento.

Los enfoques tradicionales, basados en el mantenimiento reactivo y el trabajo manual, están siendo reemplazados por estrategias innovadoras y proactivas, que buscan optimizar la eficiencia, reducir los tiempos de inactividad y garantizar el cumplimiento de estrictas normativas de higiene.
Exigencias crecientes en la fabricación de alimentos
"EL MANTENIMIENTO Y MONTAJE EN LA INDUSTRIA ALIMENTARIA HAN DEJADO DE SER PROCESOS REACTIVOS Y MANUALES. HOY EN DÍA, FORMAN PARTE DE UN ECOSISTEMA INTELIGENTE E INTEGRADO".
La producción alimentaria debe cumplir con estrictos estándares de seguridad, lo que exige equipos que no solo operen eficientemente, sino que también sean fáciles de limpiar, resistentes a la corrosión y seguros para el contacto con alimentos. Los procesos de montaje y mantenimiento deben considerar factores como la sensibilidad a la temperatura, la exposición a productos químicos y la necesidad de desmontajes rápidos. Esto impulsa la adopción de nuevas herramientas, materiales y enfoques de ingeniería centrados en la durabilidad, la seguridad y la eficiencia operativa de los equipos.
De la reparación reactiva al mantenimiento predictivo
El mantenimiento en la industria alimentaria solía ser reactivo, repa-
rándose los equipos solo cuando fallaban, lo que causaba paradas inesperadas, riesgos de contaminación y costosos tiempos de inactividad. Con la llegada de tecnologías como el Internet de las Cosas (IoT), la analítica con inteligencia artificial (IA) y los sensores inteligentes, ha surgido el mantenimiento predictivo. Gracias a estos avances, los fabricantes pueden monitorear en tiempo real variables clave como vibración, temperatura y presión, anticipando fallos antes de que ocurran.
Materiales innovadores y la seguridad en el montaje
En un sector donde la higiene es fundamental, los materiales y adhesivos utilizados en el montaje de equipos deben cumplir con estrictas normativas de seguridad alimentaria, como las de la FDA y los estándares europeos. Estos materiales deben resistir frecuentes lavados con agentes de limpieza agresivos, ser no tóxicos y garantizar una alta durabilidad. Las soluciones adhesivas innovadoras, como los adhesivos de poliuretano, están mejorando la resistencia química y la fiabilidad de las uniones en ambientes de producción exigentes, ofreciendo sellado seguro incluso
frente a ciclos térmicos, humedad y productos de limpieza.
Diseño para facilitar el desmontaje rápido
Una tendencia creciente en el mantenimiento industrial es el diseño de equipos que faciliten un desmontaje rápido. Aunque los sistemas de limpieza en sitio (CIP) son comunes, los nuevos diseños optimizan este proceso, permitiendo desmontajes sin herramientas especializadas, lo que agiliza la limpieza y reduce tiempos de inactividad. Esta modularidad también responde a la necesidad de prácticas más sostenibles, ya que los componentes fácilmente reemplazables o actualizables disminuyen los residuos y prolongan la vida útil de los equipos.
Automatización y robótica: Redefiniendo la línea de producción
La robótica ha dejado de ser exclusiva del envasado a alta velocidad y ahora se aplica en tareas de mantenimiento y montaje en las plantas alimentarias, áreas que antes dependían de mano
de obra intensiva. Estos robots realizan funciones como inspección en espacios reducidos, sellado preciso y apriete constante de pernos. Además, al reducir el contacto humano con los alimentos, mejoran la higiene y protegen la calidad del producto. Integrados con algoritmos de aprendizaje automático, estos sistemas pueden anticipar riesgos, sugerir mejoras y optimizar procesos basados en experiencias previas.
Capacitación continua de la fuerza laboral
A pesar de los avances tecnológicos, la capacitación continua es clave en la industria alimentaria. Los trabajadores deben adaptarse a nuevas herramientas y técnicas, como el uso de adhesivos específicos y la interacción con robótica. Las empresas líderes están invirtiendo en tecnologías como gemelos digitales y simulaciones, lo que mejora las habilidades del personal, reduce errores y refuerza la seguridad laboral.
Fuente: Tecnoalimen

"LA PRODUCCIÓN ALIMENTARIA DEBE CUMPLIR CON ESTRICTOS ESTÁNDARES DE SEGURIDAD, LO QUE EXIGE EQUIPOS QUE NO SOLO OPEREN EFICIENTEMENTE, SINO QUE TAMBIÉN SEAN FÁCILES DE LIMPIAR Y RESISTENTES A LA CORROSIÓN".
CAPACITACIÓN PROFESIONAL
BPM, HIGIENE Y SANEAMIENTO LEGISLACIÓN ALIMENTARIA
SUPERVISIÓN E INSPECCIÓN SANITARIA
GESTIÓN DE LA PRODUCCIÓN Y CONTROL DE PROCESOS
HERRAMIENTAS DE CALIDAD Y MEJORA CONTINUA
GESTIÓN DE CALIDAD E INOCUIDAD: ISO 2200, ISO 9001, BRC, HACCP, FOOD DEFENSE, GESTIÓN DE ALÉRGENOS, etc. CONTROL MICROBIOLÓGICO ENVASES Y EMBALAJES
REFRIGERACIÓN Y CONGELACIÓN TRATAMIENTO TÉRMICO DE ALIMENTOS
TECNOLOGÍA DE ALIMENTOS
INGREDIENTES Y ADITIVOS
ESTUDIO DE VIDA ÚTIL
EVALUACIÓN SENSORIAL EN ALIMENTOS ETIQUETADO DE ALIMENTOS CALIDAD Y TRATAMIENTO DE AGUAS


Un reciente estudio técnico detalla cómo la congelación criogénica mejora la calidad estructural, sensorial y operativa en productos de origen vegetal.

La congelación criogénica —que utiliza gases como nitrógeno líquido a temperaturas inferiores a −150 °C, ha demostrado su potencial para preservar alimentos de origen vegetal, según un Libro Blanco publicado por Carburos Metálicos. Basado en el análisis de más de 1.000 muestras, el estudio revela beneficios significativos respecto a la congelación mecánica convencional, especialmente en términos sensoriales, estructurales y económicos.
lidad en plantas de proteína vegetal premium, donde la calidad y tiempos de respuesta al mercado son determinantes.
"SE ESPERA
EL SECTOR DE PROTEÍNAS VEGETALES CREZCA UN 8,6 % ANUAL, PASANDO DE USD 18.600 MILLONES EN 2024 A USD 42.000 MILLONES EN 2034".
Uno de los hallazgos clave es que la criogenia reduce drásticamente la formación de cristales de hielo grandes, lo que minimiza el daño celular. Como resultado, los productos mantienen mejor la textura, sabor y valor nutricional al descongelarse, y se evidencia una reducción de hasta 10 veces en la pérdida de peso por deshidratación. Esto aporta un ahorro económico directo y reduce el desperdicio, un aspecto cada vez más crítico en operaciones sostenibles. En contraste, los métodos de congelación mecánica destacan por su fiabilidad y costes operativos reducidos, pero sus tiempos de congelación más largos elevan la generación de cristales gruesos, y limitan la flexibi-
El ámbito de aplicación específico para la criogenia incluye proteínas vegetales extruidas, frutas, verduras, platos preparados y productos ultracongelados (IQF), donde el control preciso de la temperatura y la estructura es esencial. El Libro Blanco subraya que esta técnica permite a las empresas responder ágilmente a lanzamientos de productos estacionales o de alto valor sensorial, mejorando la competitividad.
La relevancia del estudio está respaldada por proyecciones de mercado: se espera que el sector de proteínas vegetales crezca un 8,6 % anual, pasando de USD 18.600 millones en 2024 a USD 42.000 millones en 2034, con Europa a la cabeza. En este contexto, adoptar tecnologías de congelación avanzadas puede transformar la estrategia de conservación y distribución, alineándose con exigencias de calidad y sostenibilidad.
Fuente: Industria Química


Horario: JULIO
17, 18 y 19
Lugar:

Hora: 11:30 a.m. a 6:00 p.m.
Auditorio 2 - Centro de Exposiciones Jockey
Lima - Perú




El
El mercado de refrigeración comercial experimentará un crecimiento significativo en los próximos años, impulsado por la creciente demanda de alimentos congelados y avances tecnológicos en eficiencia energética.

creciente popularidad de alimentos congelados y listos para comer impulsa la demanda de refrigeradores y congeladores comerciales.
"LAS
MÁQUINAS DE REFRIGERACIÓN COMERCIAL SON FUNDAMENTALES PARA PRESERVAR LA CALIDAD Y SEGURIDAD DE PRODUCTOS EN SECTORES CLAVE COMO
El mercado global de equipos de refrigeración comercial se valoró en USD 49.32 mil millones en 2024 y se proyecta que seguirá creciendo, alcanzando USD 73.98 mil millones para 2032, con una tasa de crecimiento anual del 5.3%. En 2024, la región de Asia-Pacífico dominó el mercado con una participación del 26.14%. Se espera que el sector de la refrigeración comercial en Estados Unidos también experimente un crecimiento notable, alcanzando un valor estimado de USD 28.08 mil millones para 2032, impulsado por el aumento de la demanda de alimentos congelados y procesados.
Los equipos de refrigeración comercial, que incluyen congeladores, refrigeradores y máquinas de hielo, son fundamentales en diversas industrias, como la alimentaria, bebidas, comercio minorista, hotelería, restauración, así como en los sectores farmacéutico y químico. Además, las máquinas expendedoras, que se encuentran en restaurantes, supermercados y cadenas de comida rápida, también representan una parte importante del mercado.
Factores que impulsan el crecimiento del mercado de refrigeración comercial
El mercado de equipos de refrigeración comercial ha crecido de manera cons-
tante, impulsado por la reapertura del sector minorista post-pandemia y el aumento de la demanda global de bebidas carbonatadas. La creciente necesidad de refrigeradores y congeladores en supermercados para productos listos para comer y congelados, junto con el aumento del poder adquisitivo y el gasto en alimentos preparados, ha favorecido esta expansión. Además, el crecimiento del turismo ha incrementado la demanda de comidas listas para consumir, lo que seguirá impulsando las ventas de estos equipos. Según datos de la Organización Mundial del Turismo (OMT), el número de llegadas de turistas internacionales experimentó un incremento del 172% entre enero y julio de 2022, en comparación con 2019.
El impacto de la pandemia de COVID-19 afectó significativamente la demanda de equipos de refrigeración comercial a nivel mundial durante los primeros dos trimestres de 2020. La interrupción de la cadena de suministro en el sector minorista y los retos logísticos que surgieron durante este período afectaron la entrega de productos a los consumidores finales, lo que resultó en una reducción de los márgenes de ganancia para los fabricantes de equipos de refrigeración comercial.
Impacto de la tecnología en el mercado
El auge de la sostenibilidad y los avances tecnológicos están impulsando el crecimiento del mercado de equipos de refrigeración comercial. Las innovaciones como los sistemas de eficiencia energética, los refrigerantes ecológicos, y las soluciones de monitoreo inteligente están mejorando la eficiencia operativa, reduciendo los costos y asegurando la seguridad alimentaria.
La eficiencia energética ha pasado a ser una prioridad para la industria alimentaria debido al aumento de los costos de energía y la creciente conciencia ambiental. Los sistemas más recientes están equipados con tecnologías avanzadas de aislamiento, diseños optimizados de flujo de aire y capacidades de gestión inteligente de energía para reducir el consumo eléctrico.La tecnología de la Internet de las Cosas (IoT) está transformando la forma en que se monitorean y gestionan los sistemas de refrigeración comercial. Las unidades modernas incluyen sensores y capacidades de monitoreo remoto que permiten a los operadores controlar parámetros como la temperatura, la humedad y el consumo de energía en tiempo real.
Las tendencias del mercado en refrigeración comercial favorecen las soluciones modulares y personalizables, que ofrecen flexibilidad a medida que las empresas de alimentos amplían sus operaciones. Estos sistemas permiten ajustar el almacenamiento en frío y añadir unidades especializadas para diferentes alimentos. Además, los controles táctiles e interfaces intuitivas facilitan la gestión de temperatura, reduciendo la capacitación y minimizando errores, asegurando condiciones óptimas de almacenamiento.
El mercado de equipos de refrigeración comercial sigue creciendo, principalmente impulsado por la creciente demanda en la industria alimentaria, especialmente de alimentos congelados y procesados. Con un enfoque en sostenibilidad y eficiencia energética, el mercado continuará su expansión, ofreciendo nuevas oportunidades para la industria alimentaria y los fabricantes de equipos

2. Innovaciones como sistemas de eficiencia energética, refrigerantes ecológicos y monitoreo inteligente están transformando la industria.
Fuente: Fortune Business Insights











































La importancia de mantener la cadena de frío en el transporte terrestre de pescado y la propuesta de valor de JorLe Refrigeración – Thermo King
Garantizar la cadena de frío en el transporte de pescado es clave para conservar la calidad, la seguridad alimentaria, fomentar la sostenibilidad y proteger la rentabilidad de su negocio.
Autor: Karimen León Gerente de marketing

Figura 1. Flota de camiones con unidades de refrigeración de la Serie T de Thermo King. Esta serie ofrece fiabilidad, resistencia, alto rendimiento, eficiencia energética, ahorro de combustible y bajos costos de mantenimiento.
"JORLE REFRIGERACIÓN, ÚNICO
DEALER DE THERMO KING EN EL PERÚ PARA EL TRANSPORTE TERRESTRE, CUENTA CON PERSONAL ALTAMENTE CAPACITADO Y ESPECIALIZADO PARA ASESORAR A SUS CLIENTES EN LA ELECCIÓN DEL EQUIPO INDICADO SEGÚN SU APLICACIÓN, ADAPTÁNDOSE SIEMPRE A SU OPERACIÓN".
El Perú es uno de los principales países pesqueros del mundo. Desde los puertos de Callao, Paita, Chimbote, Pisco e Ilo, hasta los mercados y centros de distribución en Lima, Arequipa o Cusco, miles de toneladas de pescado se movilizan diariamente por carretera. Sin embargo, en muchos casos, esta riqueza marina enfrenta un enemigo silencioso: la ruptura de la cadena de frío durante el transporte terrestre. ¿Qué es la cadena de frío y por qué es crucial?
La cadena de frío es el sistema de conservación de productos perecederos, como el pescado, mediante temperaturas controladas desde el momento de su captura hasta su consumo final.
La cadena de frío es un elemento crítico en el transporte terrestre de pescado, ya que garantiza que el producto mantenga su frescura y sea seguro para su consumo desde el punto de origen hasta su destino final. Al tratarse de un alimento altamente perecedero, incluso pequeñas variaciones de temperatura pueden acelerar el crecimiento bacteriano, afectar su textura, sa-
bor, color, y comprometer la seguridad para los consumidores. En el caso del pescado fresco mantener una cadena de frío continua, entre 0 °C y 4 °C, no solo protege la salud del consumidor, sino que también, reduce pérdidas económicas, mejora la reputación del operador logístico, fomenta una operación sostenible y facilita el cumplimiento de normativas sanitarias nacionales e internacionales, clave para acceder a mercados más exigentes.
En Perú, aunque existen normas técnicas que regulan el transporte de productos hidrobiológicos, todavía es común ver el uso de camiones sin refrigeración adecuada, con hielo como único método de conservación. Esta práctica, aunque tradicional, ya no es suficiente para garantizar la inocuidad del pescado en trayectos largos o climas cálidos, como los de la costa norte o la selva. Asimismo, transportar pescado solo con hielo, es una práctica ineficiente y no sostenible.
Transporte refrigerado: lo que se debe hacer
La solución eficiente es el transporte en unidades refrigeradas diseña-
das específicamente para mantener temperaturas controladas. Esto implica el uso de equipos de refrigeración con control térmico automatizado, aislamiento adecuado de la cámara y monitoreo constante de la temperatura durante el trayecto. La trazabilidad y el cumplimiento de estándares internacionales también son elementos claves en esta cadena de valor. Asimismo, contar con un adecuado sistema de refrigeración para el transporte de pescado facilita la obtención de permisos sanitarios y el cumplimiento de normativas de SENASA y DIGESA, abriendo la puerta a mercados internacionales más exigentes.
En nuestra región, existen algunos buenos ejemplos. En Chile el transporte terrestre de salmón hacia mercados internacionales opera con protocolos estrictos y tecnologías de refrigeración de última generación. En Ecuador, país con creciente exportación de camarones, también se han implementado normativas exigentes que han mejorado sustancialmente la calidad del transporte refrigerado.
Propuesta de valor de JorLe Refrigeración – Thermo King
JorLe Refrigeración, único dealer autorizado de Thermo King en el Perú para el transporte terrestre cuenta con un personal altamente capacitado y especializado para asesorar a sus clientes en la elección del equipo indicado según su aplicación, adaptándose siempre a su operación.
Thermo King, es la marca líder mundial en soluciones de refrigeración para el transporte terrestre y gracias a su amplio portafolio, cuenta con un equipo para cada aplicación. Esta marca innovadora cuenta con décadas de experiencia en la conservación de productos perecibles bajo las condiciones más exigentes, con soluciones eficientes y sostenibles. Los equipos de refrigeración
Thermo King garantizan un control preciso de la temperatura durante todo el trayecto de unidades de transporte como furgonetas, camiones, semirremolques y remolques.
Los equipos de refrigeración de Thermo King son robustos, confiables, y permiten la integración con sistemas de monitoreo remoto a través de TracKing, la telemetría patentada por Thermo King. Esto facilita detectar desviaciones de temperatura en tiempo real, tomar decisiones correctivas y asegurar que la cadena de frío no se rompa. Los equipos Thermo King están diseñados para mantener la cadena de frío sin interrupciones, ofreciendo ventajas claras para el transporte de pescado en todas sus formas: fresco, refrigerado o congelado.
Conclusión
El transporte de pescado en Perú, requiere de adoptar soluciones eficientes y responsables, que aseguren la continuidad y eficacia de la cadena de frío. Invertir en transporte refrigerado no solo es una decisión técnica, sino estratégica. Protege al consumidor final de enfermedades transmitidas por alimentos contaminados, es una ventaja competitiva, es más sostenible y abre puertas a mercados más exigentes, tanto a nivel nacional como internacional.

y un control de temperatura excepcional, ¡Todo en un solo Equipo!.

el tuyo en JorLe Refrigeración.
Para más información comuníquese:
Mauricio Sáenz (+51) 960 579 424 msaenz@jorle.com.pe Nacira León (+51) 941 304 165 nleon@jorle.com.pe Web: www.jorle.com.pe
Síguenos en nuestras RRSS: Facebook: www.facebook.com/jorlerefrigeracion Instagram: www.instagram.com/jorletk/ LinkedIn: linkedin.com/company/grupo-jorle/


Con el crecimiento sostenido del consumo de productos perecederos y la presión por una logística más eficiente y sostenible, la cadena de frío enfrenta en 2025 tres desafíos clave: infraestructura envejecida, automatización obligatoria y la complejidad de la última milla. Superarlos será determinante para la competitividad operativa de las empresas del rubro alimentario.

La cadena de frío se perfila como infraestructura crítica para garantizar la seguridad y calidad de los alimentos perecederos. Sin embargo, hacia 2025, se enfrenta a tres desafíos convergentes que exigen respuestas estratégicas urgentes.
1. Infraestructura obsoleta y demanda en aumento
implican elevados costos iniciales y cierta complejidad de implementación, representan palancas de ahorro a mediano plazo y además, ya se empiezan a ver como imperativos regulatorios y reputacionales.
3. Optimización de la última milla
"EN PARALELO, EL CONSUMO DE
PRODUCTOS
FRESCOS
CRECE CON FUERZA, IMPULSADO POR CAMBIOS EN LOS HÁBITOS DE LOS CONSUMIDORES, LO QUE PRESIONA AÚN MÁS UNA RED CON TECNOLOGÍA OBSOLETA".
Gran parte de los almacenes refrigerados tiene más de 30 años de antigüedad, lo cual encarece los costos operativos, merma su eficiencia y limita la capacidad de respuesta ante picos de demanda. En paralelo, el consumo de productos frescos crece con fuerza, impulsado por cambios en los hábitos de los consumidores, lo que presiona aún más una red con tecnología obsoleta. La modernización o expansión requiere inversiones significativas y planificación de largo plazo.
2. Automatización y eficiencia energética
El “time-to-shelf” se ha convertido en un factor competitivo: los consumidores exigen frescura sin demoras. Esto obliga a adoptar tecnologías inteligentes (picking automatizado, control térmico de precisión, iluminación LED y energía solar), todo diseñado para reducir huella de carbono y costos energéticos. Aunque estos sistemas
La entrega final de productos refrigerados al consumidor representa el eslabón más vulnerable: requiere logística puntual, precisión térmica y costos ajustados al mismo tiempo. Para aliviar esta tensión, las empresas están recurriendo a depósitos colaborativos near or last-mile hubs, reutilización de espacios infrautilizados y alianzas con 3PLs especializados. Estas estrategias permiten racionalizar rutas, mejorar la eficiencia de la flota y garantizar entregas en condiciones ideales.
El panorama de 2025 exige una cadena de frío que no solo conserve calidad y seguridad, sino que además sea moderna y sostenible. La combinación de infraestructuras renovadas, robótica, tecnologías verdes y redes de distribución colaborativas será la clave para transformar estos desafíos en oportunidades de competitividad.
Fuente: The Logistic World


Normas técnicas peruanas impulsan la calidad y competitividad del café y cacao para la exportación
El Instituto Nacional de Calidad (INACAL) ha desarrollado 87 Normas Técnicas Peruanas (NTP) y 17 Guías de Implementación (GIP) para fortalecer la calidad y competitividad del café y cacao peruano en los mercados internacionales.

Figura 1. Estos avances reflejan el impacto positivo de dos cadenas productivas que concentran a más de 300 000 pequeños agricultores procedentes principalmente de las regiones de San Martín, Cajamarca, Junín, Piura, Huánuco, Amazonas, Cusco, Ucayali, Pasco y Ayacucho.
El Instituto Nacional de Calidad (INACAL) ha elaborado un total de 87 Normas Técnicas Peruanas (NTP) y 17 Guías de Implementación (GIP) orientadas a mejorar la calidad y oferta exportable del café, cacao y chocolate peruano. Estas herramientas técnicas son clave para fortalecer la competitividad del país en los mercados internacionales, especialmente ante el crecimiento de las exportaciones de ambos productos, que alcanzaron los $2400 millones en 2024.
Café:
"EL CACAO PERUANO INCREMENTÓ SUS ENVÍOS EN CASI UN 200 % RESPECTO AL AÑO ANTERIOR, MIENTRAS QUE EL CAFÉ CRECIÓ EN UN 33 %, SEGÚN CIFRAS OFICIALES".
Para el caso del café, se han establecido 38 NTP que abarcan desde las buenas prácticas agrícolas hasta métodos de análisis y criterios técnicos para sus distintas presentaciones: café verde, pergamino, tostado, molido, soluble e instantáneo. Estas normas incluyen aspectos fundamentales como los requisitos de calidad, la evaluación sensorial, el control de humedad, el contenido de cafeína y los niveles de contaminantes, garantizando así la inocuidad y calidad del producto final. Asimismo, se han desarrollado 7 GIP específicas para el café, que ofrecen orientaciones prácticas para los distintos eslabones de la cadena, desde la producción hasta la comercialización, facilitando su aplicación por parte de productores, cooperativas y exportadores.
Cacao:
En cuanto al cacao, se cuentan con 49 NTP que regulan diversos aspectos de la cadena productiva, desde la calidad del grano hasta los productos derivados: nibs, manteca, licor, cacao y chocolate. Estas normas establecen criterios sobre buenas prácticas agrícolas y de manufactura, recolección, poscosecha, muestreo, clasificación, empaque y etiquetado, así como criterios de sostenibilidad y trazabilidad, promoviendo una producción estandarizada y competitiva.
A ello se suman 10 GIP que facilitan una aplicación eficaz de estas normas promoviendo prácticas sostenibles a lo largo de toda la cadena de valor.
Es importante resaltar que el cacao peruano incrementó sus envíos en casi un 200 % respecto al año anterior, mientras que el café creció en un 33 %, según cifras oficiales. Estos avances reflejan el impacto positivo de dos cadenas productivas que concentran a más de 300 000 pequeños agricultores procedentes principalmente de las regiones de San Martín, Cajamarca, Junín, Piura, Huánuco, Amazonas, Cusco, Ucayali, Pasco y Ayacucho.
Fuente: Agroperu.pe

En Madre de Dios, un proyecto liderado por la Asociación de Castañeros de la Reserva Tambopata y Parque Nacional Bahuaja Sonene (ASCART) transforma las cáscaras de castaña en biogás para generar electricidad, mejorando los procesos de poscosecha y promoviendo la sostenibilidad en la región.
En la región amazónica de Madre de Dios, Perú, un innovador proyecto busca transformar las cáscaras de castaña, un residuo agrícola, en una fuente de energía limpia. La Asociación de Castañeros de la Reserva Tambopata y Parque Nacional Bahuaja Sonene (ASCART) ha desarrollado una iniciativa que convierte las cáscaras de castaña en biogás, el cual se utiliza para generar electricidad que alimenta motores empleados en los procesos de poscosecha.
Este proyecto, respaldado por el programa ProInnóvate del Ministerio de la Producción y la colaboración de la Universidad Nacional Amazónica de Madre de Dios, representa un avance significativo en la valorización de residuos agrícolas y la promoción de energías renovables en zonas rurales. La inversión en esta iniciativa superó los 380,000 soles, destacando el compromiso con la sostenibilidad y el desarrollo local.
La castaña (Bertholletia excelsa) es una especie nativa de los bosques amazónicos, y Perú, junto con Bolivia y Brasil, es uno de los tres países productores a nivel mundial. Madre de Dios concentra la mayor parte de la producción peruana, lo que convierte a la región en un centro estratégico para iniciativas que buscan agregar valor a este producto y promover su exportación bajo criterios de sostenibilidad.
Rosa América Chávez, presidenta de ASCART, señaló que las interrupciones del servicio eléctrico son frecuentes en la región, lo que dificulta los procesos de poscosecha. Ante esta situación, la asociación decidió buscar formas innovadoras de generar energía sin contaminar el aire ni producir ruido, respetando el entorno único y frágil de la Amazonía.
El proceso desarrollado por ASCART consiste en transformar las cáscaras de castaña en biocarbón, del cual se obtiene biogás. Este biogás se convierte en energía eléctrica para alimentar los motores utilizados en los procesos de poscosecha. Aunque el equipo se encuentra en etapa de prototipo, se espera que con las mejoras e inversiones necesarias, pueda convertirse en un aliado clave para optimizar la producción y proteger los bosques.
Además de la castaña, la región de Madre de Dios cuenta con otros recursos con gran potencial, como el copoazú, la madera de manejo sostenible y los servicios de ecoturismo. Iniciativas como esta buscan articular actores regionales para fortalecer ecosistemas de innovación y emprendimiento, promoviendo el desarrollo sostenible en el país.
Fuente: Agraria.pe

Figura 1. El proyecto en Madre de Dios convierte las cáscaras de castaña en biogás para generar electricidad, mejorando los procesos de poscosecha y promoviendo la sostenibilidad.
"LA INVERSIÓN EN ESTA INICIATIVA

El
maíz amarillo duro y el frijol: oportunidades rentables para agricultores amazónicos
El maíz amarillo duro y el frijol se perfilan como alternativas estratégicas en la Amazonía peruana, ofreciendo a los agricultores una opción rentable y sostenible en tierras fértiles.

cultivo de maíz en la región amazónica se beneficia de la alta humedad y las temperaturas constantes, lo que permite ciclos de cultivo más rápidos, facilitando una rápida rotación de cultivos y mejorando la rentabilidad agrícola.
"LA
VARIEDAD INIA 616 – UCAYALI HA DEMOSTRADO SER ESPECIALMENTE EXITOSA EN LOS SUELOS DE LA AMAZONÍA, OBTENIENDO RENDIMIENTOS DE HASTA 7 TONELADAS POR HECTÁREA BAJO CONDICIONES ÓPTIMAS Y CON EL MANEJO ADECUADO".
En las regiones amazónicas del Perú, los agricultores enfrentan diversos desafíos debido a la baja rentabilidad de cultivos tradicionales como el trigo. Sin embargo, el maíz amarillo duro y el frijol se están posicionando como opciones viables y más rentables. La característica particular de las tierras amazónicas, fértiles y con gran disponibilidad de agua, las convierte en el lugar ideal para el cultivo de estos productos, que además se adaptan bien a las condiciones climáticas locales.
El maíz amarillo duro ha ganado relevancia debido a su versatilidad y al crecimiento en la demanda para la industria avícola. La variedad INIA 616 – Ucayali ha demostrado ser especialmente exitosa en los suelos de la Amazonía, obteniendo rendimientos de hasta 7 toneladas por hectárea bajo condiciones óptimas y con el manejo adecuado. Esta variedad destaca por su resistencia a condiciones climáticas adversas, como vientos fuertes, y su capacidad de producir granos de alta calidad aptos para la industria de alimentos animales. Este tipo de maíz es ideal para el sector
avícola debido a su contenido energético y proteico, lo que lo convierte en un ingrediente clave para la alimentación del ganado.
Además, el maíz amarillo duro tiene una excelente relación beneficio/ costo. Según estudios realizados en la región, los agricultores pueden obtener una rentabilidad superior al 200% con este cultivo, lo que se traduce en más del doble de ganancias por cada sol invertido, una cifra significativamente mayor a la del trigo. Esta alta rentabilidad está impulsada por los bajos costos de producción, en comparación con otros cultivos, y la creciente demanda tanto nacional como internacional de maíz para consumo animal.
Por otro lado, el frijol es otro cultivo que está ganando terreno en la Amazonía, especialmente en sistemas agroecológicos intercalados con el maíz. Este cultivo tiene un ciclo corto y es excelente para la diversificación agrícola. Su siembra conjunta con el maíz no solo optimiza el uso de la tierra, sino que también mejora la seguridad alimentaria, tanto para el consumo hu-
mano como animal. En este contexto, el frijol se ha convertido en una fuente adicional de ingresos y proteínas, especialmente en comunidades rurales que buscan diversificar su producción y reducir el riesgo de pérdidas.
La ventaja de intercalar el maíz con el frijol es que se aprovechan mejor los recursos del suelo, promoviendo la rotación de cultivos y minimizando el agotamiento del terreno. Los agricultores amazónicos, al combinar estos dos cultivos, pueden obtener cosechas en menos tiempo y con mayor estabilidad económica. La producción de frijol también es un negocio de bajo costo, ya que las semillas son accesibles y no requiere de grandes inversiones en insumos. Además, los frijoles, ricos en proteínas, son un alimento esencial tanto para la dieta local como para la exportación.
El maíz y el frijol no sólo son rentables, sino que también son sostenibles. Ambos cultivos se adaptan bien
a las prácticas de agricultura ecológica, ya que el frijol fija nitrógeno en el suelo, mejorando su fertilidad, mientras que el maíz se puede cultivar sin necesidad de recurrir a grandes cantidades de fertilizantes químicos. Esta sinergia contribuye a la salud a largo plazo del suelo y permite a los agricultores mantener la productividad sin comprometer los recursos naturales.
Además de los beneficios económicos y ambientales, el maíz amarillo duro y el frijol son fundamentales para el desarrollo agropecuario regional. En la Amazonía, donde el acceso a mercados puede ser complicado debido a las dificultades logísticas, estos cultivos tienen la ventaja de ser de ciclo corto, lo que permite a los agricultores obtener ingresos rápidamente. Esto es especialmente importante en una región con desafíos en términos de infraestructura y transporte.
Fuente: Agroperu Informa





2. La región amazónica es ideal para cultivos como el maíz y el frijol debido a la abundancia de nutrientes naturales en el suelo, lo que reduce la dependencia de fertilizantes externos y mejora la sostenibilidad de la agricultura en el largo plazo.
"EL
FRIJOL SE HA CONVERTIDO EN UNA FUENTE ADICIONAL DE INGRESOS Y PROTEÍNAS, ESPECIALMENTE EN COMUNIDADES RURALES QUE BUSCAN DIVERSIFICAR SU PRODUCCIÓN Y REDUCIR EL RIESGO DE PÉRDIDAS".



















Técnicas innovadoras para la conservación del pan: Congelación y precocción
El pan recién horneado tiene una miga suave, corteza crujiente y un sabor único, pero estas cualidades disminuyen con el tiempo, lo cual se puede frenar con técnicas como la congelación o la atmósfera modificada.

El pan recién horneado es reconocido por su miga suave, elástica y húmeda, su corteza crujiente, y un sabor y aroma únicos. No obstante, al enfriarse después de la cocción, empieza a perder estas características debido al proceso de envejecimiento.
Congelación del pan
"EL PAN AL ENFRIARSE DESPUÉS DE LA COCCIÓN, EMPIEZA
A PERDER ESTAS CARACTERÍSTICAS
DEBIDO AL PROCESO DE ENVEJECIMIENTO CAUSANDO CAMBIOS ESTRUCTURALES EN SU TEXTURA".
El envejecimiento implica cambios estructurales en el pan que afectan su textura, sin que se trate de alteraciones microbianas. Se observa un aumento en la firmeza de la miga y una pérdida de elasticidad, debido a la pérdida de humedad y a la retrogradación del almidón, un proceso en el que las moléculas de almidón se reorganizan, perdiendo su capacidad para retener agua.
La retrogradación se ve influenciada por la temperatura, y su progresión se detiene en temperaturas de congelación. La congelación rápida del pan a -35/-40°C y su conservación posterior a -18/-20°C ayuda a preservar tanto la vida útil del pro-
ducto como a frenar su envejecimiento. Dado que la retrogradación es más rápida entre 20°C y -10°C, controlar la cinética de enfriamiento es esencial para evitar que el pan pase demasiado tiempo en estas temperaturas críticas.
A pesar de que la congelación es común en panaderías artesanas para evitar pérdidas de pan no vendido, esta técnica sigue siendo limitada, ya que los panes congelados pierden frescura al ser descongelados, afectando su calidad organoléptica.
Conservación del pan precocido
En las últimas décadas, la industria panadera ha experimentado una transformación significativa, destacando el desarrollo y crecimiento del mercado del pan precocido. Este tipo de pan, que en sus inicios en España tenía una presencia limitada en los años 80, ha ganado relevancia desde la década de 1990, especialmente en su modalidad congelada. Este aumento en la producción responde a una creciente
demanda, que se prevé continúe en el futuro, gracias a la posibilidad de terminar la cocción en el hogar. El proceso de elaboración del pan precocido se divide en dos etapas de cocción. Primero, la masa se prepara como en un proceso tradicional, aunque con algunas modificaciones en la formulación, como el tipo de harina o los aditivos. La primera cocción se realiza en la industria panadera a una temperatura aproximadamente 30°C inferior a la de un proceso tradicional de cocción. Este primer ciclo de cocción alcanza alrededor del 45% del tiempo total de cocción y no logra que la corteza tome color. Una vez completada esta primera etapa de cocción, el pan se retira del horno y se deja enfriar a temperatura ambiente. Posteriormente, se somete a un proceso de conservación que, además de evitar alteraciones microbiológicas en el pan, debe frenar su envejecimiento. Este sistema de conservación tiene como objetivo prolongar la vida útil del producto hasta el momento de su consumo.
En el momento en que el consumidor desee consumir el pan, se procede a la segunda etapa de cocción. Esta cocción final, realizada en un establecimiento o en el propio hogar, permite que el pan alcance su textura y sabor óptimos, completando así su proceso de elaboración. Esta técnica no solo asegura un pan de alta calidad, sino que también facilita la disponibilidad de pan fresco en todo momento, incluso en hogares o establecimientos sin grandes instalaciones de panadería.
Ventajas de este sistema de producción
- Pan siempre fresco para el consumidor: Este sistema permite ofrecer al consumidor pan recién cocido con su máxima calidad organoléptica, ya que el proceso de envejecimiento solo comienza una vez adquirido el pan, garanti-
zando frescura y sabor en el momento de consumo.
- Disponibilidad según demanda: Facilita la disponibilidad de pan fresco conforme a la demanda del consumidor, sin que el punto de venta necesite realizar grandes inversiones ni poseer conocimientos técnicos especializados, lo que lo convierte en una solución eficiente y accesible.
- Reducción de pérdidas por pan duro: Las pérdidas estimadas de pan duro, que alcanzan un 3% a nivel mundial, se ven notablemente disminuidas, ya que el pan se cuece bajo demanda en el punto de venta, evitando la generación de pan que se endurezca por no ser consumido.
- Congelación como técnica principal: Aunque la congelación sigue siendo la técnica más comúnmente empleada para la conservación del pan precocido, permite mantener la frescura durante un período más largo, asegurando que el pan llegue al consumidor en óptimas condiciones.
- Alternativa en atmósfera modificada: Además de la congelación, algunos productores utilizan la conservación del pan precocido envasado en atmósfera modificada (EAM), un método que implica el envasado en un entorno con una mezcla específica de gases. Este proceso ayuda a ralentizar el envejecimiento y prolongar la vida útil del pan sin necesidad de congelarlo.
- Uso extendido en Europa: La técnica de conservación en atmósfera modificada es utilizada por varias empresas panaderas en Europa, especialmente en países como Alemania, Francia y Gran Bretaña, como una alternativa eficaz para extender la frescura del pan precocido y mejorar su distribución.
Fuente: Info Alimentación
"EN LAS ÚLTIMAS DÉCADAS, LA INDUSTRIA
PANADERA HA
EXPERIMENTADO UNA TRANSFORMACIÓN SIGNIFICATIVA, DESTACANDO EL DESARROLLO Y CRECIMIENTO DEL MERCADO DEL PAN PRECOCIDO".

2. El pan precocido se elabora mediante una cocción parcial de la masa, seguida de una congelación rápida. Este proceso permite que el pan conserve su frescura y calidad organoléptica.

Figura 3. La congelación rápida del pan a temperaturas entre -35 °C y -40 °C ayuda a preservar la calidad del pan al reducir la formación de cristales de hielo grandes.

El control de calidad de la harina es vital para asegurar su adaptabilidad a diferentes procesos productivos, lo que impacta directamente en la textura, volumen y durabilidad de los productos finales.

E"LA HARINA DE TRIGO, A PESAR DE SER PERCIBIDA COMO
l control de calidad de la harina es fundamental tanto en los molinos como en la industria alimentaria, particularmente en la panificación. En los molinos, asegura que las harinas cumplan con las especificaciones requeridas y los estándares de calidad. En la industria panadera, es crucial garantizar que la harina se ajuste a las características necesarias en cada proceso, lo que permite obtener productos consistentes y de alta calidad. Este control optimiza la producción y asegura la durabilidad del producto final. La harina de trigo, a pesar de ser percibida como un ingrediente simple, es en realidad un producto altamente complejo. Sus características dependen de una serie de factores que incluyen las condiciones climáticas, la región de cultivo y las propiedades del grano. Compuesta por una mezcla de almidón, agua, proteínas, polisacáridos no almidonosos, lípidos y minerales, las proporciones de estos componentes varían según el tipo de harina, lo cual impacta directamente en su calidad y adecuación para diferentes procesos y productos. Los análisis de control de calidad proporcionan información clave sobre la idoneidad de la harina para la producción. A continuación, se presentan algunos de los parámetros más importantes evaluados en estos análisis:
Humedad: Mide la cantidad de agua en la harina. Un exceso puede promover microorganismos y reducir la vida útil del producto. El límite máximo permitido en harinas 000 y 0000 es 15 g por cada 100 g.
Cenizas: Indica el contenido de minerales y la presencia de impurezas. También refleja el proceso de molienda y el porcentaje de extracción, afectando la calidad de la harina.
Gluten: Formado por proteínas, es crucial para la formación de masa viscoelástica al ser mezclada con agua. Su cantidad y calidad determinan la textura y elasticidad del producto final.
Índice de Caída (Falling Number): Mide la actividad de la alfa-amilasa, que indica la cantidad de azúcares disponibles para la fermentación. Un valor bajo puede señalar germinación previa del trigo, afectando negativamente la calidad de la harina.
Alveograma: Evalúa las propiedades físicas y reológicas de la harina, proporcionando información sobre cómo se comporta la masa durante la panificación.
Realizar análisis de harina según el producto y proceso es clave para ajustar las masas. Los análisis periódicos, especialmente sin especificaciones, ayudan a definir rangos de aceptación y adaptar el proceso, como modificar recetas, agua o tiempo de amasado.
Fuente: Granotec
Expertos en soluciones integrales para la industria alimentaria
Neoingredients empresa dedicada a la comercialización de productos para la industria alimentaria se mantiene a la vanguardia con productos especializados y de alto valor agregado para sus clientes. Enfocados en aportar rentabilidad, calidad, optimización de procesos y formulaciones, a través de su equipo técnico especializado.
Con 14 años representando a las reconocidas marcas alemanas; Deutscheback y Mühlenchemie desarrolladores de ingredientes y productos especializados para las industrias de pani cación, pastelería, producción de pastas, premezclas y molinería; quienes, destacan por su importante aporte en la innovación de productos, tendencias globales, optimización de costos y desarrollo de ingredientes de alto rendimiento los cuales permiten mejorar características deseadas en la industria como per les de humedad, suavidad, aroma, sabores, tiempo de vida útil, entre otros.



Jr. 28 de Julio 648, Magdalena del Mar, Lima
info@neoingredients.com.pe

Representantes exclusivos en Perú de:

Entrevistada: Ing. Carol Quispe
Gerente General NEOingredients
NEOingredients se consolida como un aliado estratégico para nuestro sector alimentario, ofreciendo ingredientes de alta calidad, tecnología avanzada y soluciones sostenibles e innovadoras, mientras explora nuevas tendencias para mejorar los productos en el mercado local.
1. ¿Cuál es la misión y visión de NEOingredients?

Somos una empresa peruana que ofrecemos insumos y soporte de primer nivel a la industria alimentaria, con 14 años ininterrumpidos en el mercado.
Nuestra misión consiste en facilitar el desarrollo sostenible de nuestros clientes, a través de soluciones actualizadas con productos de alta calidad. Nuestra visión está enfocada en convertirnos en un aliado estratégico para nuestros clientes a través de la tecnología, calidad y servicios que podemos brindarles.
2. ¿Cómo reconocer un ingrediente y aditivo de calidad?
Además de los análisis fisicoquímicos que se realizan a los ingredientes para ser liberados después de su producción y validar que cumplan con las especificaciones técnicas, así como los requerimientos que exigen las normas internacionales, es trascendente e indispensable conocer al productor. Requerimos saber cuáles son sus políticas de calidad, las exigencias que tienen para cumplirlas y su reputación en el mercado global. Por ello, tenemos como principio, que no solo basta con producir, sino que hay que garantizar completamente la calidad de los productos.
3. ¿Qué valor agregado entrega NEOingredients a sus productos?
Definitivamente abrimos los ojos a la modernidad, con seguridad y determinación, al trabajar con ingredientes confiables
que mantienen siempre una misma performance del producto, lo cual ha permitido que nos mantengamos y podamos desarrollarnos en el mercado. Para lograr este objetivo, trabajamos con proveedores confiables y que cuenten con prestigio internacional, lo cual se complementa con el indispensable soporte técnico de nuestra empresa.
Considero que es lo más valioso que podemos aportar a la sociedad y a los clientes.
4. ¿Qué decisión importante ha tomado NEOingredients para su crecimiento en el sector alimentario peruano?
El trabajo conjunto con nuestros proveedores es un pilar dentro de la compañía, de ellos obtenemos mucho conocimiento y tecnología. Por otro lado, estamos apostando por la utilización de ingredientes de alto valor y eficiencia, lo cual permite mantener la sostenibilidad empresarial.
Por último, no hay que olvidar que tenemos una gran preocupación por el desarrollo tecnológico y el conocimiento técnico asertivo, ya que así mejoramos la productividad, satisfacemos necesidades y nos incorporamos en la carrera del progreso humano.
5. ¿Cuentan con iniciativas de nuevos ingredientes para el sector alimentario?
Por supuesto que sí, y se trata de innovaciones que estamos proponiendo, considerando las tendencias del mercado global a fin de incorporarlos al mercado nacional.
6. ¿Qué desafíos y oportunidades identifica la empresa en el sector alimentario y cómo pretende capitalizarlos?
Nuestra fortaleza es contar con ingredientes aptos y perdurables para lograr mejoras medibles en los productos terminados.

Estamos convencidos que en nuestros mercados hay mucha oportunidad para lograr mejores versiones de los productos que hoy existen, ya sea a través de producción, costos, fórmulas y tiempo de vida útil.
7. ¿Qué nuevas tendencias enfocamos en el sector alimentario y cómo ve el futuro de la empresa en la sostenibilidad?
Existen algunas tendencias a nivel global basados en alimentos veganos, alimentos en base a plantas, que en nuestro mercado aún son nichos de negocio. Tenemos por otro lado, consumidores en la búsqueda de alimentos agradables, saludables y con etiquetas limpias, respetando los cánones legales pertinentes, lo cual constituye otro aspecto del mercado que podemos cubrir.
Nosotros nos preocupamos y nos aseguramos de que nuestros proveedores tengan un programa de sostenibilidad social, ya sea medioambiental y en la sociedad.




La biotecnología está revolucionando la industria alimentaria, ofreciendo soluciones sostenibles y nutritivas que podrían transformar la producción de alimentos en las próximas décadas.

precisión y el cultivo celular están emergiendo como tecnologías clave en la producción de ingredientes alimentarios sostenibles, con un mercado potencial de hasta 150 mil millones de dólares para 2050.
"SEGÚN UN INFORME DE MCKINSEY, SE PROYECTA QUE LOS INGREDIENTES DERIVADOS DE PROCESOS BIOTECNOLÓGICOS REPRESENTEN ENTRE EL 4% Y EL 6% DEL MERCADO MUNDIAL DE PROTEÍNAS PARA EL 2050".
La biotecnología aplicada a la producción alimentaria está tomando un papel crucial en la transformación de la industria global. Según un informe de McKinsey, se proyecta que los ingredientes derivados de procesos biotecnológicos representen entre el 4% y el 6% del mercado mundial de proteínas para el 2050. Esto se traduce en un mercado anual estimado de entre 100 mil millones y 150 mil millones de dólares. Este impulso es por tecnologías como la fermentación de precisión y el cultivo celular, que están revolucionando la forma en que se producen ingredientes alimentarios.
Una de las grandes ventajas de estas tecnologías es su capacidad para reducir el impacto ambiental de la producción de alimentos. Al utilizar microorganismos en lugar de animales, se disminuye el uso de tierras agrícolas y las emisiones de gases de efecto invernadero. De hecho, se estima que la biotecnología alimentaria podría reducir las emisiones en un 60% en comparación con los métodos tradicionales de producción animal, lo que representa una solución clave frente al cambio climático.
No obstante, el costo de producción sigue siendo uno de los mayores obstáculos para que la biotecnología se haga más accesible. Actualmente, los costos de producción de proteínas biotecnológicas, como las obtenidas a partir de microorganismos, oscilan entre 2 y 15 dólares por kilogramo, lo que es significativamente más alto que las proteínas animales convencionales. Según estimaciones de la industria, para que los productos biotecnológicos sean competitivos a gran escala, se necesitarán inversiones superiores a 250 mil millones de dólares hasta 2050.
Estas inversiones se destinarán a mejorar la capacidad de producción, optimizar los procesos y reducir los costos de fabricación. La colaboración entre empresas biotecnológicas, actores de la industria alimentaria y gobiernos será clave para acelerar este proceso. A través de asociaciones estratégicas, compromisos de compra a largo plazo y la expansión de la infraestructura de producción, se podrá facilitar la transición hacia una producción de alimentos más sostenible.
Fuente: McKinsey & Company

























Las harinas alternativas están revolucionando la industria alimentaria al ofrecer opciones más sostenibles, nutritivas y adaptadas a diversas necesidades dietéticas.

Las harinas alternativas están ganando terreno en la industria alimentaria, impulsadas por la creciente demanda de productos más saludables, sostenibles y adaptados a diferentes necesidades dietéticas. Estas harinas, obtenidas de fuentes no tradicionales como legumbres, pseudocereales e incluso insectos, ofrecen perfiles nutricionales enriquecidos y propiedades funcionales que las hacen ideales para una variedad de aplicaciones alimentarias.
Entre las harinas más destacadas se encuentran:
- Harina de garbanzo: Rica en proteínas y fibra, es ideal para productos sin gluten y con alto contenido proteico.
también aportan beneficios funcionales como mayor retención de humedad, mejor textura y mayor vida útil. Además, su producción suele requerir menos recursos naturales, como agua y tierra, lo que las convierte en opciones más sostenibles para la industria alimentaria.
Sin embargo, la adopción de harinas alternativas también presenta desafíos. La aceptación del consumidor es un factor crítico, ya que muchos consumidores aún están acostumbrados a las harinas tradicionales y pueden mostrar reticencia a probar nuevas opciones. Además, la falta de normativas claras y consistentes en muchos países puede dificultar la comercialización de productos que contienen estas harinas.
"LA ACEPTACIÓN DEL CONSUMIDOR ES UN FACTOR CRÍTICO, YA QUE
MUCHOS CONSUMIDORES AÚN ESTÁN
ACOSTUMBRADOS A LAS HARINAS TRADICIONALES Y PUEDEN MOSTRAR RETICENCIA A PROBAR NUEVAS OPCIONES".
- Harina de quinoa: Contiene todos los aminoácidos esenciales, lo que la convierte en una excelente fuente de proteína vegetal completa
- Harina de avena: Apreciada por su alto contenido de fibra soluble, que contribuye a la salud digestiva y cardiovascular.
- Harina de insectos: Ofrece un alto contenido proteico y una huella ecológica significativamente menor en comparación con las fuentes tradicionales de proteína animal.
Estas harinas no solo mejoran el perfil nutricional de los productos, sino que
A pesar de estos desafíos, el mercado de harinas alternativas está en expansión. Según un informe de Grand View Research, se estima que el mercado global de harinas alternativas alcanzó aproximadamente 8.5 mil millones de dólares en 2021, con una tasa de crecimiento anual compuesta (CAGR) estimada de entre 7% y 8% hasta 2027. Este crecimiento está siendo impulsado por el aumento de la conciencia sobre la salud, la sostenibilidad y la demanda de productos sin gluten y de origen vegetal.
Fuente: The Food Tech







Tres jóvenes científicos españoles han desarrollado una tecnología revolucionaria que combate el desperdicio alimentario mediante etiquetas biodegradables que indican la frescura real de los alimentos.

Figura 1. Las etiquetas inteligentes desarrolladas por Oscillum cambian de color según el crecimiento bacteriano en los alimentos, proporcionando una indicación visual de su frescura y seguridad para el consumo.
"Oscillum fue reconocida entre los diez innovadores más prometedores del mundo por la Oficina Europea de Patentes, siendo los únicos españoles galardonados en los Premios Jóvenes Inventores 2025".
El desperdicio alimentario es un desafío global que afecta tanto al medio ambiente como a la seguridad alimentaria. Según la Organización de las Naciones Unidas para la Alimentación y la Agricultura (FAO), se estima que alrededor de un tercio de los alimentos producidos mundialmente se pierden o desperdician cada año. En Europa, esta cifra alcanza los 59 millones de toneladas anuales, lo que equivale a 132 kilogramos por persona. Para abordar este problema, tres jóvenes científicos españoles han desarrollado una innovadora solución: etiquetas inteligentes y biodegradables que indican la frescura real de los alimentos. Estas etiquetas reaccionan a los compuestos liberados por bacterias como Salmonella, E. coli o Listeria, cambiando de color a medida que los alimentos se descomponen. La tecnología permite a los consumidores y proveedores verificar en tiempo real si un producto sigue siendo seguro para su consumo, superando las limitaciones de las fechas de caducidad tradicionales.
La idea surgió en 2019, cuando los investigadores Pilar Granado, Pablo Sosa y Luis Chimeno, entonces estudiantes en la Universidad Miguel Hernández
de Elche, se enfrentaron a la duda de si un trozo de carne en su nevera aún era apto para el consumo. Este dilema cotidiano los inspiró a crear una solución que pudiera ayudar a millones de personas a evitar el desperdicio innecesario de alimentos.
La empresa resultante, Oscillum, ha recibido apoyo del Centro para el Desarrollo Tecnológico Industrial (CDTI) y ha participado en programas de emprendimiento como los Premios Emprende XXI de CaixaBank. Además, ha desarrollado envases activos que prolongan la vida útil de los alimentos al interactuar con su entorno.
Recientemente, Oscillum fue reconocida entre los diez innovadores más prometedores del mundo por la Oficina Europea de Patentes, siendo los únicos españoles galardonados en los Premios Jóvenes Inventores 2025 . Este reconocimiento destaca la importancia de su contribución a la reducción del desperdicio alimentario y la mejora de la seguridad alimentaria a nivel global. Etiquetas que cambian de color
Generalmente, los consumidores tienden a evaluar la frescura de los alimentos basándose en su apariencia o en las fechas de caducidad es-
tablecidas, lo que a menudo lleva a la eliminación prematura de productos que aún son aptos para el consumo. Oscillum, la empresa creada por estos innovadores, ha desarrollado etiquetas inteligentes capaces de cambiar de color según los cambios bacterianos relacionados con la descomposición de los alimentos. Estas etiquetas incorporan indicadores avanzados dentro de una matriz de polímero biodegradable.
Cuando las bacterias se multiplican, liberan sustancias que provocan un cambio visible en el color de la etiqueta. Esta reacción ofrece a los consumidores y proveedores información crucial para tomar decisiones informadas sobre la seguridad alimentaria, ayudando a reducir el desperdicio de alimentos que aún pueden consumirse. Además, estas etiquetas pueden aplicarse también a frutas y verduras, indicándose su nivel de madurez, evitando así que se descarten productos frescos por una apariencia engañosa.
La propuesta innovadora de estos tres emprendedores españoles su-
pera las limitaciones de los sistemas actuales de medición de frescura, como las etiquetas de tiempo-temperatura, que solo indican el deterioro de los alimentos relacionado con fallos en la cadena de frío. Gracias a su capacidad para analizar de manera directa el crecimiento bacteriano y los compuestos orgánicos volátiles, las etiquetas inteligentes brindan una precisión en tiempo real, adaptándose tanto a productos envasados como no envasados, incluyendo carne, pescado y otros alimentos frescos. Esta invención también contribuye a la disminución de las emisiones de gases de efecto invernadero y a la creación de un sistema alimentario más eficiente.
Con la comercialización de esta tecnología, se espera que los consumidores puedan adquirir las etiquetas directamente en supermercados, facilitando su uso en el hogar y contribuyendo a un sistema alimentario más eficiente y sostenible.
Fuente: Revista Haz

millones de toneladas de alimentos.
"LA
PROPUESTA INNOVADORA DE ESTOS TRES EMPRENDEDORES ESPAÑOLES SUPERA LAS LIMITACIONES DE LOS SISTEMAS ACTUALES DE MEDICIÓN DE FRESCURA, COMO LAS ETIQUETAS DE TIEMPO-TEMPERATURA".
Almidones nativos y modificados.
Antioxidantes, conservantes naturales y sintéticos.
Aminoácidos.
Color caramelo líquido y polvo. Cremas de licor y bebidas. emulsionadas.
Derivados de chía (fibra y omega).
Dextrosa, maltodextrina granular.
Edulcorantes: Stevia, sucralosa, fruto del monje.
Extracto de levadura (resaltador de sabor).
Extruidos proteicos.
Fibras insolubles: Trigo, avena, cacao, etc.
Fibras solubles: FOS, inulina, polidextrosa.
Funcionales: Betaglucano y extractos.
Grasas vegetales y emulsificantes.
Colágeno hidrolizado bovino
Isomaltulosa (Palatinose).
Pasta de almendras.
Polioles: Maltitol, isomalt.
Propionato de calcio y sodio.
Proteína animal: Pollo, cerdo y vacuno.
Proteína conc. y texturizada de soya.
Proteína vegetal: Arveja, haba y arroz.
Quesos en polvo.
Reductores de sodio, azúcar y grasa.
Salmueras proteicas de inyección para carnes.
Sist. Enzimáticos: pasta y molinería
Soluciones a medida: Polvoslíquidos, bases culinarias, sazonadores, etc.
Te rojo, te negro Tagatosa
Josselin.huaranca@imcdperu.com





“En este rubro lo más importante es saber escuchar al cliente”
Con más de 20 años, San Marco Perú es un socio de confianza que provee soluciones tecnológicas y maquinaria en los procesos de envasado, empacado, producción, codificado, panificación y consumibles de la industria.
Entrevistadora: Fiorella Acevedo
Entrevistada: Alana Pozzuoli



1. ¿De qué manera ha evolucionado la compañía desde sus inicios, hasta convertirse en un referente de automatización industrial?
San Marco Perú se ha enfocado en crecer, siempre pensando en ofrecer soluciones completas a nuestros clientes. A lo largo de los años hemos ido incorporando representadas con tecnología de vanguardia, la cual nos permite asesorar a los clientes y ofrecerles mejores opciones para su crecimiento y desarrollo continuo.
2. ¿Cómo San Marco Perú ha apoyado a empresas de panificación en la mejora de sus procesos?
Nosotros nos enfocamos en brindar soluciones específicas a nuestros clientes que contribuyan a optimizar sus procesos y a generar ahorros significativos.
Este acompañamiento consiste en una asesoría constante, mediante la cual no solo los guiamos en sus procesos pro-
ductivos, sino que también incorporamos equipos y maquinaria que les permiten aprovechar al máximo sus recursos.
3. ¿En qué aspectos específicos, sus soluciones ayudan a panaderías a mantener los estándares en seguridad e inocuidad?
Nuestros equipos e insumos están diseñados para cumplir con normativas internacionales de inocuidad y calidad, por ejemplo, el desmoldante Dubor cuenta con todas las certificaciones internacionales que pueden asegurarle al cliente un proceso confiable.
Los certificados con los que cuenta el desmoldante Dubor es el FSSC 22000 Halal and Kosher, entre otros.
4. ¿Qué beneficios obtiene una panadería al contar con su soporte técnico en términos de optimización?
La principal ventaja es la tranquilidad que tiene el cliente en su proceso operativo. Nosotros
vendemos equipos confiables que ayudan al cliente a enfocarse únicamente en su proceso de producción, con la seguridad de que nuestra empresa le brinda un apoyo permanente mediante mantenimientos preventivos, stock de repuestos y soporte técnico, que es lo que más necesita un cliente.
5. ¿Qué tipo de innovación ha traído San Marco Perú que ha marcado la diferencia con sus clientes?
Una de las mejores innovaciones que hemos traído para nuestros clientes de panificación es la marca Dubor. Esta marca no solo cuenta con desmoldantes, sino que también ofrece equipos de pulverizado los cuales te permiten optimizar el producto y hacer reducción en los costos. Estos equipos no solamente te ayudan a optimizar el recurso (el desmoldante) sino que también te ayudan a cumplir todas las normativas y no tengas ningún problema u observación durante posibles inspecciones.
6. ¿Qué tecnologías ha implementado San Marco Perú para mantenerse a la vanguardia en la automatización industrial?
En este rubro, lo más importante es saber escuchar al cliente. Si lo haces, conocerás sus necesidades y podrás brindarle la solución precisa para sus procesos.
Hemos crecido con marcas líderes que nos permiten apoyar a nuestros clientes con un soporte de alta calidad, que no falle durante el proceso de producción. También contamoscon un servicio técnico propio, especializado en dar mantenimiento a los equipos que ofrecemos.
Además, disponemos de stock de repuestos, lo que permite una rápida respuesta ante cualquier problema que pueda presentarse en la producción.

7. ¿Cuál es el futuro de San Marco en el mercado peruano?
Nuestro objetivo principal es seguir creciendo como aliados estratégicos de nuestros clientes, ofrecerles nuevas tecnologías y reforzar nuestra presencia regional. También tenemos previsto invertir en el soporte técnico de nuestra empresa, apostando por una automatización accesible y confiable.


Para más información comuníquese: Alana Pozzouli Curvina (+51) 994 210 110 Jefe de línea DUBOR - SMC CORPORATION S.A.C. www.sanmarcoperu.com/ alana@sanmarcoperu.com
Síguenos en nuestras RRSS: Facebook: https://www.facebook.com/ share/15vPcLGME6/ Instagram: https://www.instagram.com/ sanmarcoperu LinkedIn: https://www.linkedin.com/company/ sanmarcoperu/posts/?feedView=all


La incorporación de tecnologías como ultrasonido, plasma frío y luz UV-C optimiza la desinfección, cumple con normativas como RSA y Codex Alimentarius, y fortalece la competitividad del sector gracias a la colaboración entre industria, academia y autoridades.

La industria acuícola ha experimentado avances significativos en bioseguridad y desinfección en sus plantas de proceso, impulsados por la necesidad de cumplir con normativas internacionales y garantizar la inocuidad de los productos. La implementación de tecnologías emergentes ha permitido diversificar los métodos de sanitización, ofreciendo soluciones más sostenibles y menos agresivas para los materiales y el medio ambiente.
trechamente con normativas internacionales como el Codex Alimentarius, los lineamientos de la FDA (EE. UU.) y la EFSA (UE), que enfatizan un enfoque basado en riesgos y la aplicación de sistemas preventivos como HACCP para garantizar la inocuidad.
"TECNOLOGÍAS COMO EL ULTRASONIDO, MICRO Y NANO BURBUJAS, PLASMA FRÍO ATMOSFÉRICO (PFA), IONES HIDROXILOS, LUZ ULTRAVIOLETA (UV-C) Y ESPECIES REACTIVAS COMO OZONO HAN DEMOSTRADO ALTA EFICIENCIA MICROBIANA, REDUCIENDO LA CARGA DE PATÓGENOS".
Tecnologías como el ultrasonido, micro y nano burbujas, plasma frío atmosférico (PFA), iones hidroxilos, luz ultravioleta (UV-C) y especies reactivas como ozono han demostrado alta eficiencia microbiana, reduciendo la carga de patógenos como Listeria monocytogenes, Salmonella spp. y Vibrio spp., sin dejar residuos tóxicos. Estas innovaciones son especialmente relevantes en líneas de productos frescos y congelados, donde la inocuidad y la calidad sensorial son críticas.
La validación científica y la transferencia tecnológica han sido claves para la adopción progresiva de estas tecnologías. Además, se alinean es-
A nivel nacional, en Chile, el Reglamento Sanitario de los Alimentos (RSA) ha evolucionado para permitir enfoques tecnológicos innovadores. Por ejemplo, el artículo 174 establece que, excepcionalmente, para alimentos que favorecen el desarrollo de Listeria monocytogenes, se puede aplicar el criterio más flexible (≤ 100 ufc g-1 durante la vida útil), siempre que el fabricante o productor pueda garantizar y demostrar que el producto no superará ese límite mediante tecnologías validadas.
Estos avances refuerzan la importancia de establecer colaboraciones entre industria, academia y autoridades sanitarias para asegurar el cumplimiento regulatorio y, al mismo tiempo, mejorar la competitividad de los productos frescos y congelados en mercados exigentes.
Fuente: Aqua





Y en el área de lavado, nada puede detenerse. Por eso, traemos
NUESTRAS SOLUCIONES DE LAVADO A LIMA.






















En un contexto donde el consumidor está cada vez más informado, consciente de su salud y exigente con lo que consume, la industria de alimentos refrigerados y saludables enfrenta el reto y la oportunidad de evolucionar. En este escenario, dos conceptos se vuelven esenciales y complementarios: innovación y transparencia.
Jefe Comercial de Soluciones
Industriales - CIPTECH

La industria de alimentos refrigerados y saludables atraviesa un momento de gran expansión. Impulsada por consumidores cada vez más conscientes de su bienestar, del medio ambiente y de la procedencia de sus productos de consumo, esta categoría ha evolucionado para convertirse en un pilar fundamental del nuevo paradigma alimentario, pero detrás de cada ensalada lista para consumir, jugo prensado en frío o comida preparada a base de ingredientes naturales, hay un elemento clave que garantiza confianza: la tecnología de codificación y etiquetado.
Más allá del empaque: la trazabilidad como compromiso
cada unidad de producto: fecha de elaboración, fecha de caducidad, número de lote, ingredientes, advertencias sobre alérgenos, origen de los insumos y, cada vez más, códigos QR con trazabilidad extendida o contenido digital para el consumidor. En alimentos refrigerados, un segmento en el que la frescura y la seguridad son críticas, esta información no es solo un requisito legal, sino un mensaje de confianza.
"EN LA INDUSTRIA DE ALIMENTOS SALUDABLES, CADA DETALLE CUENTA: UN ETIQUETADO CLARO, COMPLETO Y LEGIBLE ES PARTE DE LA EXPERIENCIA DEL CONSUMIDOR Y DE SU DECISIÓN DE COMPRA".
En este nuevo escenario, los codificadores y etiquetadores de alimentos no son solo maquinaria industrial, son herramientas estratégicas que aseguran la trazabilidad, la transparencia y el cumplimiento normativo de productos que, por su naturaleza fresca y su corta vida útil, exigen una gestión rigurosa.
Estos sistemas permiten imprimir o aplicar información fundamental sobre
Para cumplir con los exigentes estándares del sector, muchas empresas están incorporando tecnologías de codificación por tinta continua, impresión láser o sistemas térmicos que permiten operar con precisión incluso en ambientes fríos o húmedos. A su vez, los etiquetadores automáticos adaptan sus formatos a empaques diversos, desde bandejas hasta botellas o bolsitas, muchas veces utilizando tintas y adhesivos sostenibles, demostrando que la tecnología va de la mano con la salud y el cuidado del planeta.
En la industria de alimentos saludables, cada detalle cuenta: Un etique-
tado claro, completo y legible es parte de la experiencia del consumidor y de su decisión de compra.
La confianza es el nuevo ingrediente estrella. Las marcas que operan en este sector de alimentos no solo ofrecen productos con menos conservantes, aditivos que resulten dañinos u otros que puedan generar el uso de octógonos, ahora también deben mostrar compromiso con la información honesta, fácilmente accesible y alineada con valores como la sostenibilidad o el comercio justo, volviendo a los sistemas de codificación y etiquetado más que herramientas técnicas, el puente entre el productor y el consumidor final.
Según tendencias sobre alimentación saludable, el mercado de alimentos refrigerados saludables crecerá a doble dígito en los próximos cinco años. Con él, la inversión en automatización, trazabilidad digital y packaging inteligente.
Porque en un mundo donde la salud es prioridad, la información también es salud. Leer una etiqueta clara, completa y confiable puede marcar la diferencia entre una compra impulsiva y una elección consciente. En CIPTECH seguimos trabajando para la incorporación de diversas tecnologías que permiten a los fabricantes de alimentos refrigerados y saludables cumplir con los estándares más altos de calidad, seguridad y trazabilidad. Estas soluciones no solo mejoran la eficiencia operativa, sino que también refuerzan la confianza del consumidor y protegen la integridad de la marca en un mercado cada vez más exigente.

"COMO
Para mayor información: Ing. Renzo Castillo Bobadilla Jefe Comercial de Soluciones Industriales - CIPTECH (511) 313 4200 Ext. 4251 (51) 998 101 314 Visítanos en: www.ciptech.com.pe
CORPORACIÓN ES NUESTRO DEBER PARTICIPAR ACTIVAMENTE CON INFORMACIÓN QUE UNE ESTOS REQUISITOS APLICANDO LA TECNOLOGÍA QUE TENEMOS PARA EL RUBRO".











Una vez se encuentran, hay muchas sinergias por descubrir. Lo mismo ocurre con la colaboración entre la multinacional sudamericana de bebidas Postobón y KHS que en un tiempo récord ha dado lugar a tres líneas de envasado monobloque.

Figura 1. Las botellas ya llenas entran en la embotelladora Innopack Kisters SP de KHS, donde se agrupan y se cubren con film retráctil.
Con más de 50 millones de habitantes, Colombia es el segundo país más grande de Sudamérica después de Brasil y uno de los mercados en crecimiento más importantes del continente. Su geografía está influenciada por las cadenas montañosas de los Andes, que alcanzan casi 6.000 metros, y unos 3.000 kilómetros de costa, dividido casi a partes iguales entre los océanos Pacífico y Atlántico. El productor de bebidas con más ventas de Colombia es Postobón, un enorme conglomerado empresarial que exporta sus productos a 27 países de todo el mundo. Su extensa y variada gama de bebidas incluye agua, refrescos, zumos, tés, bebidas energéticas, cerveza y café. Además, la empresa es licenciataria de
marcas como Pepsi, Gatorade, Mountain Dew y Seven Up, así como té Lipton y cervezas Heineken. De las 71 ubicaciones, 20 son centros de producción. Cuentan con más de 100 líneas de envasado, de las cuales 20 son para botellas PET. Las dos plantas más grandes de la compañía se encuentran en la capital y metrópoli de 10 millones de habitantes, Bogotá, y en Malambo, un suburbio de Barranquilla, en el norte del país.
La solución: tres monobloques de KHS Si anteriormente la larga relación con KHS se había limitado al suministro de máquinas de moldeo por estirado-soplado, en 2018 la embotelladora colombiana decidió por primera vez adquirir una solución monobloque: la primera línea incluye una InnoPET Triblock para agua en envases de plástico que consta de una máquina de moldeo por estirado-soplado una etiquetadora y una llenadora. Con un rendimiento de hasta 54.000 botellas por hora, desde un punto de vista técnico, la línea se distingue por la manipulación continua del cuello desde la preforma hasta el producto final embotellado. Gracias a la ayuda de los expertos del programa Bottles & Shapes, se implementó una botella que presenta un peso máximo de 10 gramos para un volumen de 600 mililitros. En la sección de secado de la línea, cabe destacar el quemador Multi-Fluid de la enfardadora Innopack Kisters SP: permite calentar el túnel de termocontracción de forma flexible con gas natural o gas propano.
Postobón quedó satisfecho con la calidad, la rapidez de la instalación y la dedicación del equipo en sitio que en un plazo de solo 18 meses encargó otras dos soluciones monobloque: la segunda línea KHS se puso en funcionamiento en Bogotá en el 2021. Se trata así mismo de una línea de envasado completa, pero su componente central es el sistema BloFill duoblock para el llenado en caliente (HotFill+) con dosificación opcional de nitrógeno para zumos, té y bebidas energéticas. Finalmente, en 2023 se ordenó en la misma planta de producción la tercera línea KHS con una máquina TriBlock para bebidas carbonatadas como Pepsi Cola. “Valoramos a KHS porque es uno de los fabricantes de instalaciones más prestigiosos a nivel mundial”, declara César Bohórquez, que en calidad de Gerente Nacional de Proyectos de Postobón es encargado de la implementación de todos los proyectos estratégicos de crecimiento. “Nos ha impresionado su nivel tecnológico de vanguardia de las líneas de alta velocidad. En el proceso de crecimiento de nuestro negocio, consideramos a KHS uno de nuestros socios tecnológicos más importantes. La empresa desarrolla soluciones integrales para nuestros requisitos de crecimiento del negocio.”
Fuente: https://competence.khs.com/es/ historias-de-clientes/hattrick-en-colombia


La filtración de agua en la industria alimentaria avanza hacia soluciones más precisas, sostenibles y automatizadas. Con sistemas capaces de reducir consumos, extender la vida útil de los equipos y garantizar inocuidad, el agua deja de ser solo insumo para convertirse en activo estratégico.

Figura 1. Sistema de filtración de lecho especial horizontal, una solución innovadora que optimiza el tratamiento de aguas residuales y de proceso en la industria alimentaria, asegurando agua limpia y segura para la producción.
En la industria alimentaria, el agua desempeña un papel fundamental en casi todos los procesos de producción, desde la limpieza de materias primas hasta el envasado y distribución de productos. La calidad del agua utilizada en estos procesos no solo afecta la eficiencia operativa, sino que también es decisiva para la seguridad alimentaria. Por ello, asegurar que el agua utilizada esté libre de impurezas, microorganismos y partículas indeseadas es una prioridad.
La tendencia actual en la filtración de agua es hacia la integración de soluciones más eficientes que, además de mejorar la calidad del agua, optimicen los procesos industriales y reduzcan los costos operativos a largo plazo.
"ESTOS SISTEMAS AVANZADOS PERMITEN OBTENER AGUA DE ALTA CALIDAD, CUMPLIENDO CON LOS RIGUROSOS ESTÁNDARES DE SEGURIDAD E HIGIENE REQUERIDOS PARA LA PRODUCCIÓN ALIMENTARIA".
Recientemente, se han dado a conocer importantes avances tecnológicos en los sistemas de filtración de agua, los cuales están revolucionando las prácticas en diversas industrias.
Estos sistemas avanzados permiten obtener agua de alta calidad, cumpliendo con los rigurosos estándares de seguridad e higiene requeridos para la producción alimentaria.
Uno de los desarrollos más significativos ha sido la evolución de los filtros de lecho especial horizontal. Estos sistemas son ideales para la filtración de aguas residuales y de proceso, ya que permiten eliminar partículas finas y otras impurezas presentes en el agua antes de ser utilizada en la producción.
Esta tecnología permite, por ejemplo, que el agua destinada a la producción de bebidas o alimentos esté completamente libre de contaminantes, garantizando la calidad y la seguridad del producto final.
En cuanto a la filtración final, las innovaciones en microfiltración
están marcando un hito en la industria. Esta tecnología se utiliza especialmente en la clarificación de líquidos como jugos de frutas, vinos, cervezas y otros productos alimentarios. Gracias a la microfiltración, es posible eliminar microorganismos y partículas en suspensión que podrían afectar la apariencia, el sabor o la estabilidad del producto, asegurando que los consumidores reciban un producto de calidad superior.
Además de la calidad del agua, otro aspecto fundamental que ha cobrado relevancia es la eficiencia en el uso de los recursos. El agua es un componente esencial en la industria alimentaria, y su calidad es crucial para garantizar productos seguros y de alta calidad. Los avances tecnológicos en sistemas de filtración de agua han permiti-
Impulsa la innovación en tu proceso productivo con tecnologías diseñadas para garantizar calidad,
normativo y el desarrollo de productos que marcan el futuro de la alimentación.
do optimizar los procesos industriales, asegurando la eliminación de impurezas y microorganismos que podrían comprometer la seguridad alimentaria. Innovaciones como los filtros de lecho especial horizontal y la microfiltración han transformado la manera en que se asegura la pureza del agua, beneficiando tanto la calidad del producto final como la eficiencia operativa. Además, estos avances contribuyen a la sostenibilidad de la industria al reducir residuos y promover un uso más eficiente de los recursos.

Figura 2. La producción de alimentos requiere grandes cantidades de agua. Se necesitan aproximadamente 15 000 litros de agua para producir un solo kilo de carne de res, una estimación que incluye el cultivo del alimento para el ganado .
Fuente: Iagua
"ESTOS SISTEMAS AVANZADOS PERMITEN OBTENER AGUA DE ALTA CALIDAD, CUMPLIENDO CON LOS RIGUROSOS ESTÁNDARES DE SEGURIDAD E HIGIENE REQUERIDOS PARA LA PRODUCCIÓN ALIMENTARIA".


Del
control manual a la automatización avanzada: El nuevo estándar en procesamiento de alimentos
La automatización en el procesamiento de alimentos impulsa la estandarización, eficiencia y calidad, fortaleciendo la competitividad del sector.
Gerente General

En la actualidad, la automatización se ha convertido en uno de los pilares fundamentales para el crecimiento sostenible de la industria. En particular, el sector agroindustrial enfrenta el desafío constante de optimizar procesos, reducir tiempos y mantener altos estándares de calidad. A esto se suma la creciente escasez y alta rotación de mano de obra directa, que impacta en la continuidad y eficiencia operativa. En este contexto, Real Steel se proyecta con una propuesta clara: la integración de soluciones tecnológicas en las líneas de procesamiento de alimentos que optimicen el rendimiento y eleven la competitividad del sector.
Importancia de la automatización en la industria alimentaria
La automatización representa un avance crucial para incrementar la productividad y asegurar la estandarización de los procesos, dos pilares fundamentales para una operación eficiente, predecible y alineada con las exigencias del sector alimentario. Además, la incorporación de tecnologías como sensores inteligentes, sistemas de visión artificial y controladores lógicos programables (PLC)
permite ejecutar cada etapa bajo parámetros estrictamente definidos, garantizando el cumplimiento de normativas sanitarias y estándares internacionales de inocuidad.
Además, la incorporación de estas herramientas posibilita la recopilación de datos en tiempo real, lo que favorece un monitoreo constante del proceso y la emisión de alertas tempranas ante cualquier desviación. Esta capacidad de supervisión no solo mejora el control operativo, sino que también permite una toma de decisiones más ágil y fundamentada, minimizando riesgos y optimizando resultados.
Sus beneficios a largo plazo son ampliamente reconocidos: reducción del consumo energético, disminución de mermas, mayor tiempo efectivo de producción y una menor necesidad de mantenimiento correctivo no planificado.
Automatización con lógica de tiempos
La automatización basada en lógica de tiempos, mediante el uso de controladores lógicos programables (PLC) permite que cada equipo dentro de una línea de proceso funcione de forma precisa y coordinada, acti-
vándose o deteniéndose según la secuencia programada. De esta manera, se logra una operación continua, mayor seguridad y menores márgenes de error.
Este enfoque permite, por ejemplo, controlar el flujo de materiales como materia prima, insumos, materiales de empaque estén disponibles en el momento oportuno, establecer pausas específicas para evitar sobrecargas o coordinar el funcionamiento simultáneo de múltiples componentes, asegurando que todo el sistema trabaje como un engranaje perfectamente alineado. El resultado es una línea de producción más segura, eficiente y adaptable a diferentes volúmenes o exigencias del mercado.
Integración de PLC en la línea de procesamiento de palta
Actualmente, Real Steel viene desarrollando pruebas y diseños preliminares para integrar controladores lógicos programables (PLC) en las líneas de proceso, con especial atención en la línea de puré de palta desde la
fruta sin cascara ni pepa hasta su envasado, pasando en forma automática por todas las operaciones como pulpeado, adición de estabilizantes, mezclado, trasiego a los tanques de vacío, aplicación de vacío y envasado respectivamente, y con ello garantiza la repetibilidad del proceso y la vida útil del mismo.
La automatización no solo mejora la eficiencia operativa, sino que redefine los estándares de calidad y productividad en el procesamiento de alimentos. Real Steel apuesta por esta transformación para fortalecer la competitividad de sus clientes. El futuro de la industria es inteligente, preciso y automatizado.

Para mayor información: Contacto comercial: Roykaninver Espinoza Torre respinoza@realsteelsac.com (51) 946048326
"LA COMPETITIVIDAD DE SUS CLIENTES. EL FUTURO DE LA INDUSTRIA ES INTELIGENTE, PRECISO Y AUTOMATIZADO".


Investigadores chinos han logrado mejorar significativamente la capacidad refrigerante de células termogalvánicas mediante electrolitos optimizados, abriendo el camino para una alternativa más eficiente, económica y ecológica a los sistemas de compresión tradicionales.

La Universidad de Ciencia y Tecnología de Huazhong (China) ha presentado un avance prometedor en refrigeración sostenible: una célula termogalvánica capaz de generar frío mediante reacciones electroquímicas, sin los gases HFC dañinos ni sistemas de compresión mecánica.
"A DIFERENCIA DE LOS SISTEMAS
CONVENCIONALES, ESTE ENFOQUE APROVECHA LA CAPACIDAD ENDOTÉRMICA DE REACCIONES REDOX PARA ABSORBER CALOR DE MANERA INVERSA, INVIRTIENDO ASÍ EL FUNCIONAMIENTO HABITUAL DE LAS CELDAS TERMOGALVÁNICAS".
A diferencia de los sistemas convencionales, este enfoque aprovecha la capacidad endotérmica de reacciones redox para absorber calor de manera inversa, invirtiendo así el funcionamiento habitual de las celdas termogalvánicas.El punto clave del avance radica en la formulación del electrolito: sal de hierro hidratada con perclorato disuelta en un solvente de nitrilo, en reemplazo del agua. Esta combinación mejora la solubilidad, movilidad iónica y la disposición de solvatación de Fe²⁺/Fe³⁺, logrando control sobre las reacciones endotérmicas y exergónicas. Como resultado, la capacidad de enfriamiento aumentó un 70 % frente a los electrolitos base agua y un prototipo preliminar alcanzó una caída de temperatura de 1,42 K, comparado con los 0,1 K de versiones anteriores.
Técnicamente, el dispositivo opera mediante dos semicírculos electro-
químicos conectados por un separador poroso: en uno ocurre una reacción endotérmica al perder electrones y absorber calor, mientras el otro libera calor al reconectar electrónicamente, disipándolo a través de un disipador térmico. La mejora en movilidad iónica es crucial para maximizar el flujo de corriente y optimizar la eficiencia del ciclo térmico.
El estudio, publicado en la revista Joule, destaca que este diseño de electrolitos es racional y universal, pudiendo adaptarse a escalas que van desde dispositivos portátiles hasta sistemas de aire acondicionado domésticos, y también centros de datos generadores de calor significativo. Aunque el factor de enfriamiento 1,42 K pueda parecer limitado, representa un salto notable en eficiencia y viabilidad económica.
No obstante, los investigadores advierten que para su implementación práctica será necesario avanzar en el diseño completo de sistemas, asegurar la estabilidad del electrolito a largo plazo y mejorar la escalabilidad.
Fuente: Cambio 16

Con un crecimiento sostenido, el mercado de equipos para procesar pescado y mariscos se ve impulsado por la automatización, la sostenibilidad y la seguridad alimentaria.
El sector de equipos para procesar pescado y mariscos ha crecido considerablemente, impulsado por la mayor demanda de productos de alta calidad y procesamiento eficiente. Se espera que este mercado supere los 4.5 mil millones de dólares en 2025, con un crecimiento anual superior al 5%. Factores como la automatización, sostenibilidad y seguridad alimentaria han acelerado la evolución tecnológica, mejorando la eficiencia, reduciendo el desperdicio y optimizando la trazabilidad. A continuación, se presentan cinco empresas destacadas en la fabricación de equipos para el procesamiento de pescado y mariscos.
Normar Trading (Noruega): Se especializa en la fabricación y restauración de equipos para el procesamiento de pescado. Ofrece soluciones tanto nuevas como reacondicionadas, lo que permite a las empresas acceder a maquinaria de calidad a precios más accesibles. Sus productos incluyen equipos para eviscerado, fileteado, congelación y empaquetado, y están disponibles en mercados clave como Sudamérica, Estados Unidos y Europa.
Baader (Alemania): Líder en tecnología para el procesamiento de mariscos y pescado, con soluciones avanzadas para fileteado, deshuesado y procesamiento integral. Destaca su sistema Baader 581 para fileteado
de pescado blanco, que maximiza el rendimiento y reduce el desperdicio. También se enfoca en la automatización y visión artificial para mejorar la eficiencia en el proceso.
Peruza (Letonia): Reconocida por sus líneas de procesamiento automatizadas, especialmente para salmón y bacalao. Se distingue por ofrecer soluciones personalizadas para sus clientes, con sistemas para clasificación, eviscerado, desespinado y empaquetado. La precisión y automatización de sus equipos optimizan el proceso de producción.
Marel (Islandia): Referente mundial en soluciones para el procesamiento de pescado industrial, Marel se destaca por su innovación, como el sistema FleXicut, que usa rayos X para eliminar espinas de filetes de pescado, mejorando el rendimiento y reduciendo el desperdicio. Su enfoque en automatización y control de calidad ha revolucionado la industria.
Carnitec (Brasil): Fabricante de equipos modulares y escalables para el procesamiento de pescado y carne. Sus soluciones incluyen sistemas de transporte, líneas de corte y congeladores, ideales para entornos industriales exigentes. Sus equipos son populares en América Latina, adaptándose a las necesidades de la industria pesquera en expansión.
Fuente: Tiempo de Negocios

"EL MERCADO DE EQUIPOS PARA PROCESAR PESCADO CRECE RÁPIDAMENTE, IMPULSADO POR LA INNOVACIÓN TECNOLÓGICA Y LA DEMANDA DE PRODUCTOS DE ALTA CALIDAD".

y eficiencia: la evolución del procesamiento y envasado de alimentos en la era digital
La industria alimentaria enfrenta desafíos clave en procesamiento y envasado: automatización, trazabilidad, sostenibilidad y seguridad alimentaria.

Figura 1. Líneas de producción automatizadas con inteligencia artificial y mantenimiento predictivo permiten un procesamiento más eficiente y con menos desperdicio.
"SEGÚN LA ASSOCIATION FOR PACKAGING AND PROCESSING TECHNOLOGIES (PMMI), MÁS DEL 60% DE LOS FABRICANTES DE ALIMENTOS EN NORTEAMÉRICA ESTÁN INVIRTIENDO EN SOLUCIONES AUTOMATIZADAS PARA REDUCIR ERRORES HUMANOS".
La industria alimentaria está experimentando una transformación impulsada por la automatización, la digitalización y las crecientes demandas de sostenibilidad. En este contexto, el procesamiento y envasado de alimentos se han convertido en eslabones estratégicos que determinan no sólo la eficiencia operativa, sino también la calidad, seguridad y competitividad del producto final.
La convergencia de tecnologías como sensores IoT, sistemas SCADA, inteligencia artificial y mantenimiento predictivo ha dado lugar al concepto de “fábricas inteligentes”. Según la Association for Packaging and Processing Technologies (PMMI), más del 60% de los fabricantes de alimentos en Norteamérica están invirtiendo en soluciones automatizadas para reducir errores humanos, optimizar tiempos de cambio y mejorar la trazabilidad. Estas líneas de producción robotizadas, con capacidad de autocalibración y ajustes en tiempo real, permiten un procesamiento más preciso y con menos
desperdicio, especialmente en entornos de producción de alta variabilidad.
Además, la implementación de tecnologías avanzadas ha facilitado la adopción de procesos de conservación no térmicos, como el procesamiento a alta presión (HPP), los campos eléctricos pulsados (PEF) y el uso de ultrasonido. Estos métodos permiten mantener la frescura, el sabor y los nutrientes de los alimentos, al tiempo que extienden su vida útil y reducen la necesidad de conservantes artificiales. Por ejemplo, el procesamiento a alta presión somete a los alimentos a presiones elevadas en un entorno frío, inactivando microorganismos patógenos sin afectar significativamente sus propiedades organolépticas y nutricionales.
En el ámbito del envasado, la sostenibilidad se ha convertido en una prioridad. Los fabricantes están adoptando materiales biodegradables e inteligentes que no solo reducen el impacto ambiental, sino que también mejoran la seguridad ali-
mentaria. Por ejemplo, los envases inteligentes pueden monitorear la calidad del producto en tiempo real y liberar compuestos activos para prevenir la degradación, como se ha demostrado en estudios recientes sobre empaques autónomos sin batería.
La trazabilidad también ha mejorado significativamente gracias a la integración de tecnologías como blockchain y la Internet de las Cosas (IoT). Estas herramientas permiten un seguimiento más preciso y seguro de los alimentos a lo largo de la cadena de suministro, garantizando su autenticidad y seguridad. La combinación de blockchain con IoT facilita la creación de registros inmutables y accesibles para todos los actores involucrados, desde el productor hasta el consumidor final.
Sin embargo, la adopción de estas tecnologías presenta desafíos. La alta inversión inicial requerida para la ad-

quisición e instalación de equipos avanzados puede ser una barrera, especialmente para pequeñas y medianas empresas. Además, la necesidad de personal capacitado con habilidades digitales avanzadas es esencial para operar y mantener estos sistemas, lo que requiere inversiones en formación y desarrollo de talento.
A pesar de estos desafíos, las oportunidades son vastas. La implementación de tecnologías avanzadas en el procesamiento y envasado de alimentos no solo mejora la eficiencia y la calidad, sino que también responde a las crecientes demandas de los consumidores por productos más seguros, saludables y sostenibles. Las empresas que adopten estas innovaciones estarán mejor posicionadas para competir en un mercado global cada vez más exigente.

"ESTAS
HERRAMIENTAS PERMITEN UN SEGUIMIENTO MÁS PRECISO Y SEGURO DE LOS ALIMENTOS A LO LARGO DE LA CADENA DE SUMINISTRO, GARANTIZANDO SU AUTENTICIDAD Y SEGURIDAD".




Después de 15 años, el gobierno peruano ha renovado el Reglamento de Ordenamiento Pesquero (ROP) para la pota, priorizando la pesca artesanal y estableciendo medidas para su sostenibilidad. Sin embargo, expertos advierten sobre la necesidad de una implementación efectiva y monitoreo continuo.

artesanales peruanos utilizan la línea potera para capturar pota, un método que favorece la pesca sostenible y minimiza el impacto ambiental.
El calamar gigante, conocido como pota (Dosidicus gigas), ha sido un pilar fundamental para la pesca artesanal en Perú. En 2023, representó el 40% de las exportaciones pesqueras del país, alcanzando un volumen récord. Sin embargo, en 2024, las exportaciones disminuyeron en un 74.8% en volumen debido a la menor disponibilidad del recurso, alcanzando solo 188,345 toneladas en comparación con las 621,852 toneladas del año anterior.
pesca ilegal, especialmente la realizada por embarcaciones extranjeras sin registro en el Sistema de Trazabilidad de Pesca y Acuicultura (Sitrapesca).
"EN 2023, REPRESENTÓ
EL 40% DE LAS EXPORTACIONES PESQUERAS DEL PAÍS, ALCANZANDO UN VOLUMEN RÉCORD".
Para abordar esta situación, el Ministerio de la Producción (Produce) actualizó el Reglamento de Ordenamiento Pesquero (ROP) después de 15 años. Una de las principales modificaciones es la exclusividad de la pesca artesanal para la pota, permitiendo únicamente el uso de la línea potera, un método selectivo que reduce el impacto ambiental en comparación con las redes de cerco mecanizado utilizadas anteriormente.
Además, el nuevo ROP establece la obligatoriedad de implementar el sistema de monitoreo satelital (Sisesat) en todas las embarcaciones artesanales dedicadas a la captura de pota. Esta medida busca garantizar la trazabilidad del recurso y combatir la
A pesar de estos avances, expertos y representantes del sector pesquero artesanal señalan desafíos en la implementación efectiva del nuevo ROP. Elsa Vega, presidenta de la Sociedad Nacional de la Pesca Artesanal (Sonapescal), destaca la necesidad de delimitar la flota artesanal para evitar la sobreexplotación del recurso y la construcción de embarcaciones en astilleros ilegales.
Asimismo, Juan Carlos Riveros, de la ONG Oceana Perú, enfatiza la importancia de establecer indicadores de desempeño y un plan estratégico que defina cómo se explotará el recurso garantizando su sostenibilidad. La falta de lineamientos claros podría comprometer los objetivos del nuevo reglamento.
Además, el impacto socioeconómico de la transición hacia la nueva normativa debe ser cuidadosamente evaluado, ya que muchas familias dependen de la actividad pesquera.
Fuente: Aqua

Perú lidera la pesca sostenible de anchoveta con una huella ambiental mínima
Un estudio publicado en la revista Aquaculture destaca que la pesca de anchoveta en Perú presenta una de las huellas ambientales más bajas a nivel global, consolidando al país como un referente en sostenibilidad pesquera.
La pesca de anchoveta en Perú ha sido reconocida internacionalmente por su compromiso con la sostenibilidad ambiental. Un análisis de ciclo de vida (ACV) realizado por Austral Group en colaboración con la Red Peruana Ciclo de Vida y Ecología Industrial (Pelcan) y publicado en la revista científica Aquaculture resalta que esta actividad presenta una de las huellas ambientales más bajas a nivel global. El estudio abarcó toda la cadena de producción, desde la pesca hasta la exportación, y comparó los impactos ambientales de la anchoveta con los de otras fuentes de ingredientes para la producción de alimentos acuícolas.
Los resultados del estudio indican que la pesca de anchoveta peruana emite significativamente menos gases de efecto invernadero (GEI) por kilogramo de producto en comparación con otras fuentes como subproductos pesqueros, soja brasileña y derivados avícolas. Esta eficiencia se atribuye a la reducción de la flota pesquera y a la menor distancia que recorren las embarcaciones para la extracción del recurso. Además, el cambio hacia una matriz energética basada en gas natural en las plantas
de procesamiento ha contribuido a una disminución significativa en las emisiones de GEI.
La Sociedad Nacional de Pesquería (SNP) destaca que la anchoveta es una de las especies más estudiadas en el mundo, lo que ha permitido implementar medidas de ordenamiento pesquero basadas en evidencia científica. Estas medidas incluyen el uso del Sistema de Seguimiento Satelital (SISESAT) para monitorear las operaciones de la flota pesquera y la implementación de un programa de vigilancia y control de la pesca y el desembarque. Estas acciones han sido fundamentales para garantizar la sostenibilidad de la pesquería y evitar la pesca ilegal. Además, el Perú ha avanzado en la certificación de la pesquería de anchoveta bajo el estándar del Marine Stewardship Council (MSC), lo que reconoce las buenas prácticas de manejo y sostenibilidad en la industria pesquera. Este logro es el resultado de un esfuerzo conjunto entre el sector público y privado, que ha trabajado en el Proyecto de Mejora (PROME) para alcanzar un estatus certificable para la pesquería de anchoveta.
Fuente: Aqua

" LA SOCIEDAD NACIONAL DE PESQUERÍA (SNP) DESTACA QUE LA ANCHOVETA ES UNA DE LAS ESPECIES MÁS ESTUDIADAS EN EL MUNDO, LO QUE HA PERMITIDO IMPLEMENTAR MEDIDAS DE ORDENAMIENTO PESQUERO BASADAS EN EVIDENCIA CIENTÍFICA".

El Ministerio de la Producción actualiza el reglamento sanitario para pesca y acuicultura, precisando obligaciones, tipificando nuevas infracciones y estableciendo mecanismos de cooperación interinstitucional.

1. SANIPES juega un rol clave en la implementación del nuevo reglamento pesquero, garantizando la calidad e inocuidad de los productos pesqueros a través de la fiscalización y la certificación en todo el proceso productivo.
"EN CUANTO A LOS PROCEDIMIENTOS
ADMINISTRATIVOS,
EL NUEVO REGLAMENTO
ESTABLECE
EL PROCESO
PARA
LA
EJECUCIÓN DE DECOMISOS, DISTINGUIENDO ENTRE RECURSOS DESTINADOS AL CONSUMO HUMANO DIRECTO E INDIRECTO".
El Ministerio de la Producción (Produce) del Perú ha aprobado un nuevo decreto que modifica el reglamento sanitario para la pesca y acuicultura, con el objetivo de fortalecer la fiscalización, mejorar la trazabilidad y reducir la burocracia en el sector. Esta actualización introduce cambios significativos en la tipificación de infracciones, la clasificación de sanciones y los procedimientos administrativos, buscando una gestión más eficiente y sostenible de los recursos hidrobiológicos.
Una de las principales modificaciones es la actualización de más de 50 numerales del artículo 134 del Reglamento de la Ley General de Pesca. Se han incorporado nuevas infracciones relacionadas con actividades extractivas sin autorización, uso de equipos no permitidos y omisión en la incorporación de fiscalizadores o personal técnico durante las faenas. Además, se han tipificado como muy graves conductas como la presentación de documentación falsa, extracción de especies protegidas, uso de materiales tóxicos y desembarques sin medios de preservación adecuados, generando la descomposición del recurso.
En el ámbito del procesamiento, comercialización y transporte, se han establecido infracciones específicas, como procesar productos sin licencia vigente, superar los porcentajes de pesca incidental permitida y almacenar recursos extraídos en zonas de veda. Estas medidas buscan garantizar la trazabilidad y la calidad de los productos pesqueros en todo su ciclo productivo.
La nueva normativa también introduce una clasificación más detallada de las infracciones en muy graves, graves y leves, en función de su impacto sobre la sostenibilidad de los recursos. Esta clasificación incide directamente en la determinación de sanciones, que pueden incluir multas, decomisos, suspensiones o cancelaciones de licencias, entre otras medidas. Además, se han actualizado las reglas para la aplicación de reincidencias, determinando sanciones progresivas según el número de veces que se cometa la misma infracción dentro de plazos determinados. En casos reiterados, se contempla la suspensión o cancelación de derechos administrativos como el permiso de pesca o la licencia de operación.
En cuanto a los procedimientos administrativos, el nuevo reglamento establece el proceso para la ejecución de decomisos, distinguiendo entre recursos destinados al consumo humano directo e indirecto. También se detalla el cálculo del valor comercial del recurso en caso de incumplimiento y los pasos para su disposición final. Estas disposiciones buscan garantizar una gestión transparente y eficiente de los recursos incautados.
La cooperación interinstitucional es otro aspecto clave de la actualización normativa. Se faculta al Ministerio de la Producción a compartir con el Servicio Nacional de Áreas Naturales Protegidas por el Estado (SERNANP) información obtenida a través del Sistema de Seguimiento Satelital (SISESAT), con el fin de reforzar la fiscalización en áreas naturales protegidas. Esta medida busca mejorar el control en zonas sensibles y prevenir actividades ilegales que puedan afectar la biodiversidad marina.
Además, se han establecido mecanismos para reducir la burocracia en el
sector pesquero. Se han simplificado los procedimientos administrativos, eliminando requisitos innecesarios y agilizando los trámites para los operadores pesqueros. Estas acciones buscan fomentar la formalización y mejorar la competitividad del sector, facilitando el cumplimiento de las normativas y promoviendo buenas prácticas en toda la cadena productiva.
La implementación efectiva de estas modificaciones dependerá de una adecuada capacitación y sensibilización de los actores involucrados, así como de una fiscalización eficiente y coordinada entre las instituciones competentes.
Es fundamental que los operadores pesqueros comprendan las nuevas disposiciones y se comprometan con su cumplimiento, contribuyendo así a la sostenibilidad de los recursos marinos y al desarrollo responsable del sector.

2. El sistema SISESAT permitirá un monitoreo más efectivo de las embarcaciones pesqueras, mejorando la trazabilidad y fortaleciendo el control sobre las actividades extractivas en áreas protegidas.
"ESTAS
ACCIONES BUSCAN FOMENTAR LA FORMALIZACIÓN Y MEJORAR LA COMPETITIVIDAD DEL SECTOR, FACILITANDO EL CUMPLIMIENTO DE LAS NORMATIVAS Y PROMOVIENDO BUENAS PRÁCTICAS".




Nestlé revoluciona el envasado con un envase biodegradable hecho de suero de queso
Nestlé ha presentado Self-Packing Cheese, un envase innovador hecho de suero de queso, un subproducto que antes se desechaba, ofreciendo una alternativa sostenible en el envasado.

Figura 1. "Self-Packing Cheese" se está probando como sustituto del empaque primario y secundario en la línea de quesos Nestlé ¡Qué Rico! distribuidos en Panamá.
EL PROYECTO "SELFPACKING CHEESE" DE NESTLÉ Y OGILVY COLOMBIA REPRESENTA UN AVANCE SIGNIFICATIVO
Nestlé ha lanzado una innovadora solución en el ámbito del envasado sostenible: el "Self-Packing Cheese". Este proyecto, desarrollado en colaboración con Ogilvy Colombia, utiliza el suero de queso, un subproducto comúnmente desechado, para crear un envase biodegradable que reemplaza al plástico convencional. El proceso implica transformar el suero en un biopolímero conocido como PHA (polihidroxialcanoatos), que comparte propiedades similares al plástico pero es completamente biodegradable.
Este avance no solo reduce los residuos plásticos, sino que también aprovecha un recurso previamente infrautilizado en la industria láctea. El envase desarrollado es flexible, translúcido y cumple con los estándares de seguridad alimentaria establecidos por la FDA (Food and Drug Administration). Además de ser funcional, este material permite imprimir información sobre el producto, manteniendo intactas las propiedades nutricionales, el sabor y la frescura del queso. La empresa tiene como objetivo producir hasta 5,500 toneladas de queso con este empaque biodegradable, demostrando un compromiso claro con la economía circular en Centroamérica.
Esta iniciativa forma parte de un esfuerzo más amplio para reducir el impacto ambiental en la industria alimentaria. Nestlé ha identificado la necesidad de innovar en los procesos de producción y empaque para alinearse con los Objetivos de Desarrollo Sostenible y satisfacer la creciente demanda de los consumidores por soluciones más ecológicas.
El proyecto no solo busca resolver el problema del plástico de un solo uso, sino que también impulsa un modelo de producción más responsable y circular.
La colaboración con Ogilvy Colombia, a través de su "Impact Lab", ha sido fundamental en el desarrollo de este proyecto. Este laboratorio se centra en crear soluciones creativas que integren sostenibilidad, tecnología e innovación, y "Self-Packing Cheese" es un claro ejemplo de su enfoque. El impacto potencial de esta innovación va más allá del queso. “Self-Packing Cheese" demuestra ser exitoso y escalable, podría servir como modelo para otros productos alimentarios y sectores industriales que buscan soluciones sostenibles para el envasado.
Fuente: Diario Gestión

El packaging de alimentos está siendo transformado por la sostenibilidad, digitalización y las crecientes demandas del consumidor, dando lugar a tendencias clave que redefinen su diseño, producción y uso en toda la cadena de valor.
Las marcas, en su esfuerzo por destacarse en un mercado competitivo, están reconociendo al packaging como un factor estratégico esencial. Esto se debe a que las tendencias actuales, impulsadas por consumidores más exigentes y conscientes, buscan soluciones que minimicen el impacto ambiental, favoreciendo el uso de materiales naturales, biodegradables y compostables, así como sistemas reutilizables que promuevan la circularidad.
Todo esto responde tanto a las regulaciones más estrictas como a los objetivos de sostenibilidad de las empresas. Es por ello que te presentamos las tendencias más relevantes en el packaging de alimentos, que están marcando el rumbo hacia un futuro más innovador y responsable en la industria:
Plataformas conectadas: La digitalización está transformando el packaging de alimentos con plataformas conectadas que usan tecnologías como códigos QR, etiquetas NFC y sensores IoT para ofrecer información en tiempo real sobre frescura, trazabilidad y nutrición. Un ejemplo es el uso de blockchain para detallar el ciclo de vida del producto, y sensores que alertan sobre riesgos en productos perecederos.
El cambio hacia la paperización: La paperización, que reemplaza los plásticos por materiales celulósicos en el packaging, se está consolidando como una tendencia hacia envases más sostenibles. Aunque el papel y cartón son reciclables y tienen una buena percepción ecológica, su adopción enfrenta desafíos, especialmente al no ofrecer las mismas barreras que el plástico contra humedad, grasas y oxígeno.
Soluciones naturales en materiales de empaque: La creciente demanda de materiales sostenibles ha llevado al uso de packaging basado en recursos naturales como la celulosa, que es biodegradable, reciclable y mejora la vida útil de los alimentos. Además, las algas marinas, especialmente las pardas, se presentan como una opción prometedora debido a su rápido crecimiento sin necesidad de agua dulce ni fertilizantes.
Expansión de productos reutilizables: La industria del packaging de consumo enfrenta una creciente presión para cumplir con los rigurosos objetivos de sostenibilidad, impulsados por la demanda de los consumidores y las regulaciones para reucir la huella de carbono y los desechos.
Fuente: The Food Tech

están emergiendo como una alternativa innovadora y sostenible al
en la industria del packaging alimentario.
"EL PACKAGING COMO CLAVE





FOODTECH INGREDIENTS
Fecha: Del 17 al 19 de julio de 2025
Lugar: Centro de Exposiciones Jockey, Lima - Perú
Web: www.expoingredients.com/

EXPO PERÚ INDUSTRIAL
Fecha: Del 21 al 23 de agosto de 2025
Lugar: Centro de Exposiciones Jockey, Lima - Perú
Web: www.expoperuindustrial.com/
SEPTIEMBRE

EXPO PESCA
Fecha: Del 03 al 05 de septiembre de 2025
Lugar: Centro de Exposiciones Jockey, Lima - Perú
Web: www.thaiscorp.com/expopesca/

EXPOALIMENTARIA
Fecha: Del 24 al 26 de septiembre de 2025
Lugar: Centro de Exposiciones Jockey, Lima - Perú
Web: www.expoalimentariaperu.com/

EXPO AGUA Y SOSTENIBILIDAD
Fecha: Del 16 al 18 de octubre
Lugar: Centro de Exposiciones Jockey, Lima - Perú Web: www.expoaguaperu.com/

FERIA INTERNACIONAL DE ENERGÍAS RENOVABLES, EFICIENCIA ENERGÉTICA E ILUMINACIÓN SOSTENIBLE
Fecha: Del 27 al 29 de noviembre Lugar: Centro de Exposiciones Jockey, Lima - Perú Web: https://eeeperu.com/

EXPOCHINA
Fecha: Del 29 al 01 de noviembre DEL 2025 Lugar: Centro de Exposiciones Jockey, Lima - Perú
Web: www.expochina.pe









FI SOUTH AMERICA 2025
Fecha: Del 26 al 28 de agosto de 2025
Lugar: São Paulo Expo | São Paulo - Brasil Web: www.fi-events.com.br/

ANUGA 2025
Fecha: Del 04 al 08 de octubre de 2025
Lugar: Cologne, Alemania Web: www.anuga.com

CHINA FISHERIES & SEAFOOD EXPO
Fecha: Del 29 al 31 de octubre de 2025
Lugar: Qingdao-China Web: https://chinaseafoodexpo.com/

FOIRE INTERNATIONALE ET GASTRONOMIQUE DE DIJON 2025
Fecha: Del 01 al 11 de noviembre
Lugar: Parc des Expositions et Congrès de Dijon Web: www.foirededijon.com/

LES AUTOMNALES 2025
Fecha: Del 07 al 16 de noviembre Lugar: Palexpo Web: https://www.automnales.ch/

VIETNAM EXPO - HOCHIMINH CITY 2025
Fecha: Del 04 al 06 de diciembre Lugar: Saigon Exhibition & Convention Center - SECC Web: https://hcm.vietnamexpo.com.vn/en/


